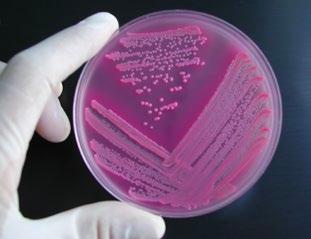
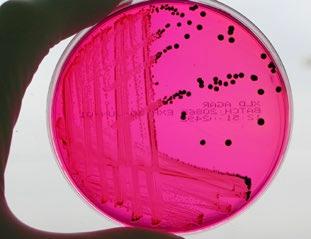
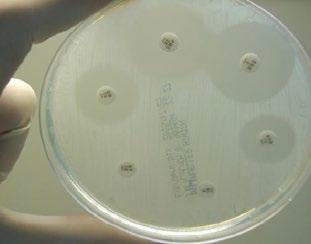

HEPIZOVAC PRIMERA VACUNA

![]()


Dosis: 4 ml
Pauta de vacunación: Dos dosis (separadas 3 semanas)
Revacunación anual
HEPIZOVAC suspensión inyectable para bovino.
Presentaciones: 100 ml y 252 ml
Composición por dosis (1 ml): Virus inactivado de la enfermedad hemorrágica epizoótica (VEHE), serotipo 8, 105.5 DICC50 Indicaciones y especies de destino: Para la inmunización activa de bovino para prevenir la viremia y para reducir los signos clínicos causados por el virus de la enfermedad hemorrágica epizoótica. Vía de administración: Subcutánea. Posología: Dosis: 4 ml. Pauta de vacunación: A partir de los 2 meses de edad. Administrar dos dosis de 4 ml con un intervalo de 3 semanas. Revacunación: Se recomienda una revacunación anual. Contraindicaciones: Ninguna. Precauciones: Conservar y transportar refrigerado (entre 2ºC y 8ºC). No congelar. Proteger de la luz. Tiempo de espera: Cero días. Medicamento sujeto a prescripción veterinaria. Titular de la autorización de uso temporal (Art. 110.2, Reglamento (UE) 2019/6): CZ Vaccines S.A.U. A Relva s/n-Torneiros. 36410 O Porriño. Pontevedra.
En caso de duda consulte a su veterinario
El sector de los rumiantes se encuentra en una encrucijada en la que convergen la necesidad de eficiencia productiva, el bienestar animal y la sostenibilidad.
Cada decisión, desde la gestión nutricional hasta la gestión sanitaria, tiene implicaciones que van más allá del rendimiento inmediato, influyendo en la resiliencia de los sistemas ganaderos y su capacidad de adaptarse a un entorno en constante evolución.
La salud de los animales no puede considerarse de manera aislada. Por ejemplo, el equilibrio del eje intestino-hígado y la transición digestiva en fases críticas, como el destete , afectan a la capacidad productiva a lo largo de toda la vida del animal.
De igual manera, enfermedades como la criptosporidiosis o el complejo respiratorio bovino exigen estrategias de control que integren bioseguridad, inmunización y un uso racional de antimicrobianos.
La creciente preocupación por las resistencias a los antibióticos nos recuerda que el tratamiento de enfermedades no puede depender solo de fármacos, sino de una visión integral de la sanidad animal.
El bienestar animal también se está redefiniendo. Las nuevas tecnologías permiten monitorizar en tiempo real indicadores clave, como la temperatura corporal de las
En el caso del sacrificio, alternativas como los mataderos móviles ofrecen una solución innovadora para reducir el impacto del transporte en el bienestar de los animales, sin perder de vista la calidad del producto final.
Por otro lado, la sostenibilidad ya no es una opción, sino un requisito ineludible.
La gestión de residuos y la normativa sobre envases son parte de un nuevo marco regulatorio que obliga a repensar la economía del sector bajo principios de circularidad.
Al mismo tiempo, la optimización en el uso de minerales esenciales como el fósforo no solo mejora la eficiencia productiva, sino que también mitiga su impacto ambiental, asegurando que los recursos sean gestionados con responsabilidad.
En este contexto, el futuro de la ganadería de rumiantes dependerá de la capacidad para integrar ciencia, tecnología y manejo de manera equilibrada.
No se trata de elegir entre producción y bienestar, o entre rentabilidad y sostenibilidad, sino de encontrar la manera en que cada elemento contribuya a la solidez del sistema productivo.

EDITOR
GRUPO DE COMUNICACIÓN AGRINEWS S.L.
PUBLICIDAD
Laura Muñoz
+34 629 42 25 52 laura@mediatarsis.com
Félix Muñoz +34 618 18 00 16 felix@mediatarsis.com
Luis Carrasco +34 605 09 05 13 lc@agrinews.es
DIRECCIÓN TÉCNICA
Christian de la Fe Rodríguez Luis Miguel Jiménez Galán
REDACCIÓN
Daniela Morales
COLABORADORES
Gema Chacón
Fernando Bacha Braulio de la Calle Campos
María Fernández
ADMINISTRACIÓN
Mercè Soler
Tel: +34 93 115 44 15 info@grupoagrinews.com www.rumiantes.com
Precio de suscripción anual: España 30 € Internacional 90 €
DIRIGIDA A VETERINARIOS DE RUMIANTES
Depósito legal rumiNews B-8798-2019
ISSN (Revista impresa): 2696-8185
ISSN (Revista digital): 2696-8193
Revista trimestral
La dirección de la revista no se hace responsable de las opiniones de los autores. Todos los derechos reservados. Imágenes: Noun Project / Freepik/Dreamstime/BioRender
4

Desafíos y adaptaciones fisiológicas del destete en rumiantes: función intestinal y hepática
Fernando Bacha Nacoop, S.A.
El destete en rumiantes implica cambios en la función intestinal y hepática, afectando su metabolismo y adaptación nutricional.
10
16

Barreras invisibles: el eje intestino-hígado y su impacto en la salud de los rumiantes
Víctor Sáinz de la Maza-Escolà, DVM, PhD Especialista en Rumiantes Vetagro
Fósforo en la nutrición de rumiantes: eficiencia productiva y marco regulador
Braulio de la Calle Campos
DT Rumiantes Coren Agroindustrial SAU y responsable Departamento Vacuno de Carne en Coren Sociedad Cooperativa
Optimizar el fósforo en la dieta de los rumiantes es clave para mejorar la producción y reducir su impacto ambiental.
26

Monitoreo continuo de temperatura en vacas: clave para afrontar el estrés por calor
Israel Flamenbaum Ph. D.
Cow Cooling Solutions, Ltd, Israel
32
38
MASTERFLY® BAIT: control eficaz de moscas hasta 8 meses
Servicio Técnico de Quimunsa
Nueva normativa de envases y residuos: ¿cómo afecta al sector ganadero y a los productores?

Diego Calvo Director de Reysa
La normativa de envases y residuos introduce nuevas obligaciones para productores y gestores en el sector ganadero.
44 51



El secreto está en el ciclo: decálogo sobre la criptosporidiosis en los terneros
Carlos Carbonell y Laura Elvira Equipo Técnico de MSD Animal Health
Resultados de etiología y sensibilidad antibiótica en procesos digestivos en bovino
Silvia del Caso, Cristina Baselga y Gema Chacón Exopol S.L.
El estudio de sensibilidad antibiótica en bovino permite optimizar tratamientos frente a patógenos digestivos y mejorar el control sanitario.
Mycoplasma bovis incrementa su papel clínico-epidemiológico en el complejo respiratorio bovino










60 Juan Carlos Corrales1 , Xóchitl Hernández1 , Juan Alcázar2 , Antonio Sánchez1 , Joaquín Amores1 , Antonio Fernández 3 , Ginés Luján3 , Elena Hernández 3 , David del Olmo 4 , Héctor Ramírez 5 , Ana Martínez-Expósito 4 , Alejandro Sánchez 5 y Christian de la Fe1*



1Grupo de Investigación Sanidad de Rumiantes, Departamento de Sanidad Animal, Facultad de Veterinaria, Universidad de Murcia.
2Responsable técnico veterinario de rumiantes de CARGILL SL.
3ADS de Bovino de Lorca.
4Juan Jiménez García S.A.U.
5Bos Nostrum S.L.
Mycoplasma bovis juega un papel creciente en el complejo respiratorio bovino, afectando la sanidad y el manejo en cebaderos.





Vacunación frente al ectima contagioso: Un reto por resolver 78





Álex Gómez1,2 , Idoia Glaria3 , Irati Moncayola3 , Irache Echeverría4 , Ana Rodríguez-Largo5 , Laura Arriazu3 , Ainhoa Calero3 , Estela Pérez1,2 , Lluís Luján1,2 y Ramsés Reina3
1Departamento de Patología Animal, Universidad de Zaragoza
2Instituto Agroalimentario de Aragón-IA2, Universidad de Zaragoza
3Instituto de Agrobiotecnología (CSIC-Gobierno de Navarra)
4Departamento de Agronomía, Biotecnología y Alimentación, Universidad Pública de Navarra
5Servei de Diagnòstic de Patologia Veterinària, Departament de Sanitat i Anatomia
Animals, Universitat Autònoma de Barcelona
La vacunación frente al ectima contagioso sigue siendo un desafío y su desarrollo requiere enfoques innovadores para mejorar la protección en los pequeños rumiantes.



69 84




Linfoma multicéntrico en una oveja
David Guallar1 , Ibai
Tamayo1 , David López1 , María Villacampa1 , Maialen Zinkunegui1 , Héctor Ruiz1,2 y Pablo Quílez1,2
1Servicio Clínico de Rumiantes, Facultad de Veterinaria de Zaragoza
2Departamento de Patología Animal, Universidad de Zaragoza
El linfoma multicéntrico en ovejas es una enfermedad poco común, cuyo diagnóstico requiere un enfoque clínico y patológico detallado.




Evaluación del impacto de los mataderos móviles de cordero en el bienestar animal, calidad de la carne y huella de carbono
Xavier Puigvert1 , Alba Piqué2 , MSc. Anna Aymerich3 y Dr. Carles Gasol4
1Ingeniero Agrónomo, Universidad de Girona
2Veterinaria. Técnica de Proyectos. Asociación de iniciativas Rurales y Marítimas de Cataluña (ARCA)
3Responsable de proyectos de métricas ambientales en Inèdit (Consultoría ambiental)
4Director de desarrollo de negocio en Inèdit (Consultoría ambiental)
Los mataderos móviles ofrecen una alternativa para reducir el estrés en corderos y optimizar la logística en pequeñas explotaciones.
Agradecemos a nuestros anunciantes por hacer posible la publicación de esta revista: Bioplagen, Instalaciones Agropecuarias Cosma, Intracare, Lidervet, Miavit, MSD Animal Health, Quimunsa, Reagro, Vetia Animal Health y Zoetis.
Fernando Bacha Nacoop, S.A.

Una gran parte de los nutrientes absorbidos por el intestino de los rumiantes son modificados o utilizados durante la fermentación microbiana en el intestino delgado y también por los tejidos absorbentes del ternero antes de su liberación a la circulación.
Esto da como resultado una disminución en el suministro de energía y precursores de aminoácidos de una fuente de alimento determinada que están disponibles para los tejidos productivos.
Este uso de energía y aminoácidos no puede considerarse como una pérdida total, ya que los tejidos intestinales absorbentes realizan un servicio vital para el resto del organismo. Por tanto, representa una disminución de la eficiencia productiva por unidad de energía alimenticia suministrada.
Por necesidad funcional, el intestino y el hígado están colocados anatómicamente para tener acceso a los nutrientes absorbidos antes que los tejidos periféricos. El metabolismo intestinal y hepático determinan la disponibilidad de la mayoría de los nutrientes para el desarrollo de las funciones productivas, siendo cruciales para la salud y el crecimiento.
De hecho, el sistema porta (tracto digestivo, páncreas, bazo, grasa omental y grasa mesentérica) solo representa el 8-10 % de los tejidos corporales, pero consume el 18-25 % del O₂ del animal, con un 25 % adicional representado por el hígado.
Si bien una parte de la energía gastada por el epitelio intestinal está directamente asociada con el coste de absorber y transportar activamente nutrientes para su uso posterior, la mayor parte se utiliza para el mantenimiento de la integridad y masa de los tejidos. Estas funciones incluyen principalmente:
La actividad de Na+ -K+ -ATPasa.
La síntesis y degradación de proteínas.

Sin embargo, definir el coste real de los tejidos intestinales es complejo por el hecho de que su masa cambia en respuesta al plano de nutrición, la composición química de la dieta y el estado fisiológico del animal.
La mayor parte de las investigaciones se han centrado en el papel de la leche y los factores de crecimiento del calostro en el desarrollo intestinal neonatal de los rumiantes, pero hay escasez de datos que describan la respuesta intestinal y ruminal durante el destete.
La masa ruminal responde excepcionalmente al cambio en la forma de la dieta, lo que probablemente refleja el éxito de la derivación del sustituto de la leche más allá del rumen y la interrupción del establecimiento de una fermentación ruminal.
Aunque los cambios en la masa intestinal no son evidentes, la capacidad de asimilación de nutrientes puede verse afectada.
Esto sugiere que el crecimiento ruminal responde al suministro de sustrato energético, pero el crecimiento del tejido intestinal no.


Tomados en conjunto, estos datos muestran que el crecimiento intestinal no depende simplemente una función del suministro de sustrato energético o de la composición química de la dieta, sino más bien de un conjunto de aportes nutricionales y fisiológicos.

A pesar de que el hígado neonatal y pre-rumiante representa un mayor porcentaje de peso corporal vacío que el del rumiante adulto, la fracción del uso de oxígeno de todo el cuerpo atribuida al hígado es considerablemente menor.
Esto nos deja claro que existe una menor actividad metabólica.
El aumento en la actividad metabólica hepática en la vida adulta del animal probablemente refleja los cambios en la cantidad y el tipo de sustratos metabolizados por el hígado, por ejemplo, glucosa y ácidos grasos frente a AGV, como consecuencia del desarrollo del rumen.
En los animales en desarrollo, la adaptación digestiva antes del destete de un pre-rumiante a un rumiante funcional coincide con un cambio de la glucosa absorbida principalmente por el intestino, los ácidos grasos de cadena larga y los aminoácidos derivados de la leche a AGV, cetonas, aminoácidos de fuentes microbianas y de piensos, y otros compuestos dietéticos.
En consecuencia, este cambio en el patrón y suministro de nutrientes de la dieta provoca alteraciones sustanciales en la función hepática y el reparto de energía que requieren procesos como la síntesis de glucosa y de proteínas, el mantenimiento de gradientes iónicos, el ciclo del ácido cítrico, de la urea y la desintoxicación de compuestos.
Para aclarar los mecanismos hepáticos implicados en este período de transición, la mayoría de las investigaciones han intentado determinar si el hígado pre-rumiante está totalmente adaptado a la llegada de cualquier producto procedente del intestino delgado o si experimenta un proceso de maduración propio en respuesta al desarrollo ruminal.
El mayor cambio en los principales procesos metabólicos durante el desarrollo ruminal es el cambio de un hígado glucolítico a glucogénico (Tabla 1).


Enzima Especie Pre-rumiante Rumiante adulto
Vía de las pentosas
Glucosa-6-fosfato deshidrogenasa Bovino + -
6-Fosfoglucanato deshidrogenasa Bovino + -
Glicolisis
Hexocinasa Ovino + -
Fructosa-1,6-bisfosfato aldolasa Bovino + -
Gliceraldehido 3-fosfato deshidrogenasa Bovino + -
Piruvato cinasa Ovino SC SC
Ciclo del ácido tricarboxílico
Citrato sintasa Ovino SC SC
Malato deshidrogenasa Ovino SC SC
Gluconeogénesis
Glucosa 6-fosfatasa Bovino - +
Fructosa-1,6-bisfosfato Ovino - +
Piruvato carboxilasa Ovino + -

Lactato deshidrogenasa Ovino + -
Metabolismo del glucógeno:
Glucógeno sintetasa Ovino + -
Glucógeno fosforilasa Ovino + -
Metabolismo de las cetonas
β-hidroxibutirato deshidrogenasa Ovino - +
Acetil-CoA acetiltransferasa Ovino - +
Acetil-CoA sintetasa Ovino SC SC
1: (+) = Aumenta la actividad enzimática; (-) = Disminuye la actividad enzimática; (SC) = Sin cambio la actividad enzimática
Tabla 1. Cambios en la actividad enzimática hepática con el cambio en las prioridades metabólicas asociadas al desarrollo ruminal (Adaptado de: Baldwin, R.L.; 2004; J. Dairy Sci. 87:(E. Suppl.) E55-E65 ).
Como ya hemos visto, a medida que aumenta la fermentación microbiana, hay menos carbohidratos disponibles para la digestión postruminal y el suministro dietético de glucosa disminuye.
Existe una reducción básica en la capacidad enzimática para la oxidación de la glucosa hepática. El tejido hepático deberá soportar el aumento de las necesidades de glucosa del animal al mismo tiempo que una disminución en la glucólisis.
Esto da como resultado un rápido aumento de la actividad gluconeogénica hepática al mismo tiempo que el desarrollo ruminal.

Las diferencias en el suministro de nutrientes portales de pre-rumiante y rumiantes al hígado, también modifican la regulación hormonal de la función hepática.
A medida que avanza el desarrollo ruminal, hay una disminución de la sensibilidad de la gluconeogénesis hepática en respuesta a altas concentraciones de insulina y glucagón.
Se ha demostrado que la actividad de la glucosa 6-fosfatasa se duplica (o más) durante el período del destete.
Los pre-rumiantes pueden convertir el lactato o el propionato en glucosa. La inhibición de la gluconeogénesis del lactato en los rumiantes adultos es probablemente el resultado de una mayor disponibilidad de propionato.
El cambio en el metabolismo hepático hasta convertirse en gluconeogénico puede ser una respuesta al desarrollo del rumen funcional que genera un suministro continuo de sustrato glucogénico en forma de propionato.
En hepatocitos aislados de pre-rumiante, el glucagón aumenta efectivamente la gluconeogénesis a partir de propionato y lactato, pero no tuvo ningún efecto sobre los hepatocitos de rumiantes adultos.
Las reservas hepáticas de glucógeno del pre-rumiante suelen igualar o superar los niveles de los adultos. Sin embargo, un ayuno corto de 16 horas resulta en el consumo de casi todo el glucógeno hepático, mientras que ayunos similares tuvieron poco efecto sobre el glucógeno hepático en adultos.
Una vez más, debido a que el pre-rumiante experimenta cambios muy enérgicos de patrones postprandiales de entrega de nutrientes, es necesario un amplio control hormonal de la gluconeogénesis hepática. El rumiante funcional recibe en el hígado un suministro más continuo de sustratos glucogénicos y es un productor constante de glucosa; por lo tanto, requiere menos control hormonal.

Una de las características principales del intestino delgado funcional en animales no preñados y no lactantes, es la producción ruminal de cetonas.
En un rumiante adulto no preñado y no lactante, es el intestino delgado el principal productor de cetonas, mientras que el intestino delgado del pre-rumiante produce cantidades insignificantes de cetonas.
Esto se debe a la ausencia de fermentación microbiana, siendo el hígado es el sitio principal de la cetogénesis.
En el caso de ayunos prolongados, el pre-rumiante es capaz de realizar la cetogénesis hepática casi desde el momento del nacimiento, pero no se realiza habitualmente. El desarrollo del rumen tiene un impacto claro e importante y se han realizado varios estudios para dilucidar los mecanismos que controlan la diferenciación ruminal y a pesar del esfuerzo todavía no se comprenden satisfactoriamente.
Desafíos y adaptaciones fisiológicas del destete en rumiantes: función intestinal y hepática
DESCÁRGALO EN PDF
No hay suficiente evidencia para decidir cuál de ellos es el más importante: si es el control ontogénico o bien son los factores nutricionales y endocrinos los reguladores de este importante momento. Pareciera ser la combinación de todos ellos.
Aquí muy probablemente esté la respuesta al por qué en la práctica hay algunos aditivos que funcionan en algunas ocasiones y en otras no.
Más claro está que el desarrollo intestinal ocurre durante el período fetal y perinatal siendo un control ontogénico casi en su totalidad, aunque, la capacidad de transporte de nutrientes cambia, ya que el animal pre-rumiante se convierte en rumiante como resultado de los nutrientes específicos suministrados.
En el rumiante en crecimiento, los efectos dietéticos, es decir la ingesta sobre la masa ruminal e intestinal, alteran claramente las necesidades de proteínas y de energía de mantenimiento. Estos cambios en la masa intestinal afectan a las capacidades digestivas y de absorción.
Los cambios fundamentales en las vías metabólicas ocurren en el hígado como consecuencia del desarrollo del rumen, y pueden ser responsables del aumento de las necesidades energéticas asociados con la función hepática de los rumiantes maduros en comparación con el hígado de los pre-rumiantes.
Víctor Sáinz de la Maza-Escolà, DVM, PhD
Especialista en Rumiantes Vetagro

La salud intestinal es un aspecto fundamental en la productividad y bienestar de los rumiantes lecheros.
Históricamente, la investigación en salud digestiva de los rumiantes se ha centrado en el rumen, dejando en un segundo plano el papel del intestino delgado y su interacción con el hígado.
Sin embargo, recientes estudios han demostrado que este eje es clave para la regulación metabólica, inmunológica y digestiva.
A pesar de su importancia, hasta la fecha se ha explorado poco su impacto en la producción lechera.
Recientes ensayos han permitido medir por primera vez la permeabilidad intestinal en vacas lecheras, arrojando información clave sobre la relación entre inflamación y productividad.
En este contexto, el uso de ingredientes botánicos y ácidos orgánicos microencapsulados se ha estudiado como una estrategia para mejorar la integridad intestinal y modular la respuesta inflamatoria.


En los rumiantes, el intestino delgado no solo es responsable de la absorción de nutrientes, sino que también actúa como una barrera selectiva contra patógenos y toxinas.
A su vez, el hígado juega un rol crucial en la gluconeogénesis, el metabolismo de lípidos y la detoxificación.
La comunicación entre ambos órganos se da a través de la circulación enterohepática, un sistema bidireccional que permite al intestino influir en el hígado y viceversa.
El hígado secreta ácidos biliares primarios, inmunoglobulina A y angiogenina al tracto gastrointestinal, contribuyendo a mantener la eubiosis intestinal y limitar el crecimiento de bacterias patógenas.
A su vez, la microbiota intestinal participa en la biotransformación de estos ácidos biliares primarios en secundarios, modulando su función y facilitando la absorción de grasas.
Disruptores intestinales
1 2 3
Señalización in amatoria
DETOXIFICACIÓN
Destete y estrés social por reagrupamiento de los factores in amatorios Ácidos biliares
Dietas ricas en almidón y baja calidad de forraje
Estrés térmico

Figura 1. Eje intestino-hígado en rumiantes. Los disruptores intestinales, como el estrés postdestete, las dietas ricas en almidón y el estrés térmico, favorecen la translocación de toxinas y bacterias a través de la mucosa intestinal. Estas toxinas, mediante la circulación entero-hepática, pueden sobrecargar la capacidad detoxificadora del hígado, causando daño hepático e inflamación sistémica, lo que se traduce en una reducción del consumo de materia seca y del rendimiento productivo.
Circulación entero-hepática
Toxinas y bacterias
DAÑO HEPÁTICO
INFLAMACIÓN SISTÉMICA
Consumo de materia seca
Rendimiento
Cuando la integridad intestinal se ve comprometida, ya sea por cambios en la dieta, estrés térmico o factores ambientales, se produce un fenómeno conocido como "intestino permeable" (leaky gut en inglés).
Esto permite el paso de endotoxinas y productos microbianos hacia la circulación sistémica, generando una activación inmunológica y un mayor consumo de energía para la respuesta inflamatoria, lo que afecta negativamente a la producción de leche y al bienestar animal.

La microbiota intestinal desempeña un papel esencial en la homeostasis del eje intestino-hígado.
A través de la fermentación de la fibra dietética, se producen ácidos grasos de cadena corta, como el butirato, que fortalecen la barrera intestinal y proporcionan energía a los enterocitos.
Sin embargo, alteraciones en la microbiota, causadas por dietas inadecuadas, enfermedades o cambios ambientales, pueden favorecer la proliferación de bacterias patógenas y la producción de metabolitos tóxicos que afectan la salud hepática.
Diversos factores pueden comprometer la integridad del eje intestino-hígado en rumiantes:
Dietas ricas en almidón y baja calidad de forraje: pueden generar acidosis subaguda ruminal, afectando a la microbiota y debilitando la barrera intestinal. El exceso de almidón fermentable disminuye el pH ruminal, promoviendo la proliferación de bacterias productoras de endotoxinas.
Factores sociales y ambientales: prácticas como el destete, el transporte y la reagrupación pueden inducir estrés, alterando la fisiología digestiva y comprometiendo la salud intestinal.
Estrés térmico: se ha demostrado que el calor excesivo daña la morfología intestinal y aumenta la permeabilidad, favoreciendo la endotoxemia. Durante períodos de altas temperaturas, los rumiantes experimentan una redistribución del flujo sanguíneo desde el intestino hacia la piel para disipar calor, lo que reduce el aporte de oxígeno y nutrientes a la mucosa intestinal, aumentando el riesgo de disbiosis.
Enfermedades metabólicas: condiciones como la cetosis y la lipidosis hepática afectan el metabolismo energético, incrementando la vulnerabilidad del eje intestino-hígado.
Ante estos desafíos, se han explorado diferentes alternativas nutricionales para mitigar el impacto de la inflamación en rumiantes.
La suplementación con ingredientes botánicos y ácidos orgánicos microencapsulados ha demostrado efectos positivos sobre la salud digestiva y el metabolismo hepático en varias especies (Rossi et al., 2020; Fontoura et al., 2023) y han sido propuestos como alternativa a los antibióticos promotores del crecimiento en especies monogástricas (EFSA, 2012).


Compuestos como el ácido cítrico y sórbico reducen el pH gastrointestinal, limitando el crecimiento de bacterias patógenas y equilibrando la microbiota. Además, modulan la expresión de genes inmunitarios, mejorando la resistencia a infecciones.
El ácido cítrico optimiza la producción de energía en el ciclo de Krebs y reduce el estrés oxidativo, mientras que el ácido sórbico posee propiedades antimicrobianas que afectan la viabilidad de bacterias gram negativas, contribuyendo a una mejor salud digestiva.
Sustancias como el timol y la vainillina, tienen propiedades antioxidantes, antiinflamatorias e inmunomoduladoras, fortaleciendo la barrera intestinal.
Sus compuestos fenólicos pueden inhibir el factor nuclear kappa B (NF-κB), reduciendo la producción de citoquinas proinflamatorias y disminuyendo la inflamación intestinal.
Permite que estos compuestos pasen por el rumen sin degradarse, llegando al intestino delgado donde ejercen sus efectos.
La tecnología de microencapsulación protege los ingredientes activos de la degradación microbiana en el rumen y optimiza su liberación en el tracto digestivo inferior (Lobo et al., 2023a,b).
Estudios recientes realizados en la Universidad de Cornell (Estados Unidos) han demostrado el impacto positivo de la suplementación con ingredientes botánicos y ácidos orgánicos microencapsulados en la salud intestinal y la producción lechera.
En un estudio con terneros expuestos a estrés térmico, la suplementación con ingredientes botánicos y ácidos orgánicos microencapsulados mejoró el consumo de materia seca (+200 g/animal/día) y la ganancia de peso (+100 g/animal/día) en comparación con el grupo control (Fontoura et al., 2023).
En vacas en media lactación sometidas a condiciones de estrés por calor en un ambiente controlado, la inclusión de ingredientes botánicos y ácidos orgánicos microencapsulados en la dieta redujo la permeabilidad intestinal, medida a través de la concentración plasmática de un marcador de paracelularidad (Cr-EDTA).
También se observó una menor presencia de LBP (proteína de unión a lipopolisacáridos) y SAA (amiloide sérico, proteína de fase aguda), lo que sugiere una menor translocación de endotoxinas y una mejor respuesta inmunitaria (Sáinz de la MazaEscolà et al., 2023).
En el mismo ensayo se observó un incremento en consumo de materia seca (+1,4 kg/d), un aumento de producción de leche (+2,7 kg/d), y también mejora de los sólidos en leche (Fontoura et al., 2022; Gráficas 1 y 2).

Producción de leche
SEM = 0,64
ET-Control vs. TN-Control, P<0,01
ET-Control vs. ET-Tratamiento, P<0,14
TN: Termoneutralidad (THI = 68)
ET: Estrés térmico (THI = cambio diurno de 74 a 82)
Día del experimento
TN-Control ET-Tratamiento ET-Control
Gráfica 1. Consumo de materia seca en vacas expuestas a estrés por calor y suplementadas con ingredientes botánicos y ácidos orgánicos microencapsulados (Fontoura et al., 2022).
En condiciones de campo bajo estrés por calor, el uso de ingredientes botánicos y ácidos orgánicos microencapsulados se ha testado en varios escenarios.
En vacas frescas, se registró un descenso en la temperatura rectal (0,5 °C) y un incremento significativo en la producción de leche (+2,4 kg/d), junto con una mejora en proteína en leche (Sáinz de la MazaEscolà et al., 2022).
En vacas en media lactación, se observó un aumento en la producción de grasa y en la eficiencia de conversión (Thomas et al., 2025).
En cabras lecheras se observó un aumento en la leche corregida por energía y en la grasa de la leche (Giorgino et al., 2023).
SEM = 0,64
ET-Control vs. TN-Control, P<0,01
ET-Control vs. ET-Tratamiento, P<0,14
TN: Termoneutralidad (THI = 68)
ET: Estrés térmico (THI = cambio diurno de 74 a 82)
0 1 2 3 4 5 6 7 8 9 10 12 13 14 11
Línea basal
Día del experimento
TN-Control ET-Tratamiento ET-Control
Gráfica 2. Producción de leche en vacas expuestas a estrés por calor y suplementadas con ingredientes botánicos y ácidos orgánicos microencapsulados (Fontoura et al., 2022).
El eje intestino-hígado es un sistema clave en la salud y productividad de los rumiantes lecheros.
Mantener su integridad es esencial para optimizar la eficiencia productiva y minimizar las consecuencias del estrés y los desafíos ambientales.
El uso de ingredientes botánicos y ácidos orgánicos microencapsulados representa una estrategia prometedora para mejorar la salud intestinal y hepática, reduciendo la inflamación y promoviendo el bienestar y el rendimiento animal.
Barreras invisibles: el eje intestino-hígado y su impacto en la salud de los rumiantes DESCÁRGALO EN


Braulio de la Calle Campos
DT Rumiantes Coren Agroindustrial SAU y responsable Departamento Vacuno de Carne en Coren Sociedad Cooperativa



En los animales, aproximadamente el 80 % del fósforo presente en el organismo se encuentra en los huesos y dientes que, además de brindar soporte estructural, actúan como una reserva de este mineral.

En el caso de los rumiantes, el fósforo es, además, necesario para el funcionamiento del microbiota del rumen, donde la importancia de este elemento es doble.

La presencia de fitasas y fosfatasas microbianas en el rumen les permite aprovechar gran parte del fósforo fítico presente en los vegetales.
En este sentido, la actividad
El 20 % restante está distribuido en otros componentes, donde desempeña funciones esenciales en procesos biológicos como:
La transferencia de energía.
El transporte de ácidos grasos volátiles (AGV).
La síntesis de proteínas.
El equilibrio ácido-base.
La división y multiplicación celular.
El metabolismo del nitrógeno en vacuno lechero está estrechamente relacionado con el aporte de fósforo, ya que una ingesta insuficiente de este mineral afecta a la fermentación ruminal, lo que se traduce en una menor síntesis de proteína microbiana y una reducción en la digestibilidad de los

absorción del fósforo ocurre principalmente en el intestino delgado, pudiendo ser:
Retenido para funciones productivas.
Secretado en el lumen intestinal, donde puede ser reabsorbido o eliminado en las heces.
La homeostasis del fósforo se regula principalmente a través del reciclaje en la saliva y la excreción fecal endógena.
Por ello, la estimación de su digestibilidad basada únicamente en la diferencia entre la ingesta y la excreción carece de valor en la evaluación de este nutriente.
Figura 1. Diagrama del metabolismo del fósforo en rumiantes. El fósforo ingerido pasa al rumen y al tracto gastrointestinal, donde parte es absorbido y distribuido a través del plasma hacia los huesos y tejidos blandos.
También se recicla a través de la saliva y se elimina principalmente por la orina y las heces, regulando así su homeostasis en el organismo.
Ingestión de P
Rumen

Tracto
Orina
Tejidos
Blandos
Excreción de P
Dada su importancia en el mantenimiento de las funciones biológicas, una deficiencia en los aportes de fósforo puede conllevar serios efectos negativos.
Los primeros signos de deficiencia de fósforo suelen ser inespecíficos y, por ello, no siempre se identifican de inmediato.
Si la deficiencia persiste, los animales presentarán anorexia y pérdida de peso. Además, según su estado productivo, pueden presentarse problemas como:
Disminución de la fertilidad.
Retrasos en la concepción.
Menor producción de leche. Entre ellos, se encuentran la reducción del consumo y la eficiencia en la utilización del alimento, lo que conlleva una merma en el ritmo de crecimiento.
También pueden observarse fenómenos de pica* o alteraciones del comportamiento.
*Trastorno del comportamiento en el que los animales ingieren sustancias no nutritivas o inusuales, como tierra, madera, huesos o plásticos. En rumiantes, suele estar asociado a deficiencias nutricionales, como la falta de fósforo, sodio o fibra efectiva, y puede afectar su salud y rendimiento productivo.


Para prevenir su déficit, el fósforo se incorpora de manera rutinaria en piensos y raciones a través de fuentes minerales, principalmente fosfatos de origen mineral, como meta, piro u ortofosfatos.
Además, este macromineral puede estar presente en los alimentos de origen vegetal, animal o mineral, lo que influye en su disponibilidad y aprovechamiento por parte del animal.
En la actualidad, el fósforo se considera un factor clave en los procesos de eutrofización de suelos y ecosistemas acuáticos.
Un aumento en su concentración en estos entornos favorece el crecimiento excesivo de materia vegetal, lo que dificulta la transmisión de la radiación solar, reduciendo la fotosíntesis y el nivel de oxígeno en el agua.
Paralelamente, aumenta la actividad de los microorganismos descomponedores de materia orgánica y, con ello, el consumo de oxígeno.
Exceso de fósforo

PBloqueo de la radiación solar
Sobrecrecimiento materia vegetal
Deficiencia de oxígeno
Estos cambios alteran las condiciones del ecosistema, disminuyendo la diversidad biológica y afectando la fauna acuática.
Proliferación de microorganismos descomponedores de materia orgánica
PÉRDIDA DE BIODIVERSIDAD
Figura 2. Proceso de eutrofización en ecosistemas acuáticos debido al exceso de fósforo. El aporte excesivo de este nutriente provoca un crecimiento descontrolado de la materia vegetal, lo que bloquea la radiación solar y reduce la fotosíntesis. Como consecuencia, disminuye la concentración de oxígeno en el agua, favoreciendo la proliferación de microorganismos descomponedores y generando una pérdida de biodiversidad en el ecosistema.
Desde un punto de vista ambiental, es fundamental ajustar el contenido de fósforo en las raciones para evitar un aporte excesivo, ya que los animales lo eliminan al medio, generando un impacto significativo en los ecosistemas.
¡No todo el fósforo ingerido es absorbido!
En el caso de forrajes verdes de praderas permanentes o cereales, la absorción alcanza aproximadamente el 70 %, mientras que en los cereales en grano llega al 75 %.
El fósforo absorbido que no es retenido en los tejidos o productos es eliminado a través de la orina o reciclado al tracto digestivo mediante la saliva, para ser finalmente reabsorbido o expulsado en las heces.
La cantidad de fósforo eliminado a través de la orina aumenta conforme aumenta el aporte del mineral, pero representa una proporción muy pequeña respecto al fósforo eliminado en las heces, donde se elimina fósforo de diferentes procedencias, lo que da lugar a diferentes fracciones:
El fósforo aportado por el alimento que no ha sido absorbido.
El fósforo asociado a las secreciones digestivas y a las células del tracto digestivo que se desprenden de la pared.
El fósforo asociado a la población microbiana que se elimina en las heces.
El fósforo reciclado con la saliva y que no ha sido reabsorbido o utilizado por la población microbiana.
La excreción de fósforo al medio aumenta a medida que se incrementa su ingesta. Sin embargo, este aumento proviene principalmente del fósforo ingerido que no ha sido absorbido, ya que la excreción endógena, conocida como "pérdidas inevitables", se mantiene relativamente constante.
Hasta hace relativamente poco, la formulación de dietas se ha basado en amplios márgenes de seguridad, lo que, en muchos casos, ha resultado en un aporte excesivo de fósforo.

Mantener unos niveles óptimos de fósforo en la dieta es fundamental, ya que favorece la fertilidad, el consumo de alimento, la producción de leche y la salud ósea. Además, en animales en crecimiento, una ingesta adecuada de este mineral previene la deformación del esqueleto y garantiza una eficiencia alimentaria óptima.
Para preservar la salud de los animales y optimizar tanto la producción lechera como el crecimiento, es esencial ajustar correctamente los niveles de fósforo en la dieta.

Actualmente, gracias a los sistemas modernos de racionamiento y al uso de criterios de nutrición de precisión, resulta más sencillo afinar la formulación mineral y evitar excesos innecesarios.
Las recomendaciones sobre el aporte de fosfato varían considerablemente. Sin embargo, se considera que una ración con un promedio de 3,5 g de fósforo/kg de materia seca es suficiente para una vaca lactante con una producción de 10.000 kg de leche.
A modo de referencia, pueden seguirse las siguientes pautas nutricionales:
Terneros pequeños: 3,4 g/kg MS
Terneros mayores y novillas: 2,3 g/kg MS
Vacas secas: 2,0 g/kg MS
Vacas lecheras:
Producción de 20 kg de leche: 2,5 g/kg MS
Producción de 40 kg de leche: 3,3 g/kg MS
Producción de más de 40 kg de leche: 3,5 g/kg MS
La mayoría de las dietas se sitúan dentro de un rango de 0,32-0,38 g de fósforo por cada 100 g de materia seca, en línea con las recomendaciones actuales del NRC para vacas de raza Holstein, dependiendo principalmente del nivel de producción de leche.
Sin embargo, un porcentaje significativo de las raciones supera los 0,38 g/100 g MS, lo que puede resultar en excreciones de fósforo superiores a 60 g/día por animal.
Este exceso no solo representa un desperdicio económico, sino que también tiene un impacto ambiental considerable, especialmente si los purines o el estiércol no se gestionan adecuadamente, contribuyendo a la contaminación del suelo y del agua.
La reducción del fósforo en la dieta de las vacas lecheras debe realizarse sin comprometer su rendimiento productivo, siendo fundamental asegurar un aporte adecuado que permita el funcionamiento óptimo del rumen, especialmente en la digestión de la celulosa.

Una ingesta insuficiente de fósforo puede afectar la tasa de fermentación ruminal, disminuyendo la digestibilidad de los nutrientes y reduciendo la eficiencia en la producción de proteína microbiana.
Como consecuencia, tanto el metabolismo como la utilización del nitrógeno pueden verse afectados por un nivel inadecuado de fósforo en la dieta.
En los últimos años, numerosos estudios han analizado los requerimientos de nitrógeno y fósforo en el vacuno lechero con el objetivo de minimizar su excreción. Sin embargo, la mayoría de estas investigaciones han evaluado un nutriente de forma aislada, manteniendo fija la concentración del otro.
Para abordar esta limitación, un grupo de investigadores de China llevó a cabo un estudio en el que se analizó el efecto de la variación simultánea de los niveles de proteína y fósforo en la dieta.
Los resultados revelaron que reducir la proteína bruta del 17 % al 15 % y el fósforo del 0,44 % al 0,34-0,39 % no afecta el consumo de alimento, la digestibilidad, la fermentación ruminal, la producción lechera ni los metabolitos plasmáticos.
Esto sugiere que es viable reducir los niveles de proteína y fósforo en la dieta como estrategia para disminuir la excreción de estos nutrientes sin comprometer el rendimiento animal.
REGULACIÓN Y SOSTENIBILIDAD: NORMATIVA SOBRE LA GESTIÓN DEL FÓSFORO
El Real Decreto 1051/2022, de 27 de diciembre, por el que se establecen normas para la nutrición sostenible en los suelos agrarios consolida los cambios anunciados en la gestión de purines y fertilizantes, regulando cómo, cuándo y cuánto fósforo puede aplicarse en los terrenos agrícolas.
El objetivo principal de esta norma es reducir las emisiones de gases, especialmente amoníaco, y prevenir la contaminación del agua y el suelo.
CAMBIOS INTRODUCIDOS POR LA NORMATIVA:
Si el titular de la explotación realiza la valoración agronómica de los estiércoles en el suelo, deberá contar con superficie agrícola suficiente, ya sea propia o concertada.
La cantidad de estiércoles aplicados deberá ajustarse a lo dispuesto en el Real Decreto 47/2022, de 18 de enero, calculando el contenido de nitrógeno del estiércol con base en las tablas zootécnicas para el balance de nitrógeno y fósforo.

Cálculo obligatorio de las necesidades de nitrógeno y fósforo, con la recomendación de incluir también el potasio.
Obligatoriedad de un plan de abonado explotaciones.
Durante cinco años consecutivos, aportes efectivos calculados para el nitrógeno y en más de un 20 % para el fósforo y el potasio.
Con 2,5 UGM de vacuno por hectárea, no sería necesario adquirir fertilizantes adicionales de fósforo y potasio.

En los últimos años, la regulación ambiental en la Unión Europea ha impulsado medidas más estrictas para reducir el impacto de la ganadería en el medio ambiente.
En este contexto, Holanda ha implementado un plan de reducción de fosfatos con el objetivo de disminuir las emisiones derivadas de la producción lechera. Sin embargo, esta estrategia conlleva importantes consecuencias para el sector, afectando tanto el censo ganadero como la producción de leche.
El Plan de reducción de fosfatos prevé una disminución de la producción de leche entre un 6 % y un 10 %, así como una reducción del censo de vacas en un 6 %.
El Gobierno de La Haya ha diseñado
Según estimaciones del USDA, esta estrategia ambiental podría provocar una reducción del 6,6 % en el censo de vacas lecheras, situándolo en 2,27 millones de animales.
Así, dependiendo de las medidas que adopten los productores para cumplir con los objetivos, la producción de leche holandesa podría disminuir entre un 6 % y un 10 %.
Para alcanzar los objetivos de reducción de fosfatos propuestos, el plan se estructura en varias medidas clave, cada una con un impacto directo en la producción ganadera y el censo de vacas lecheras.

Reducción de fosfatos en el sector lácteo (4 millones de kg de fosfatos)
Los productores de leche estarán obligados a reducir su producción o el tamaño de sus rebaños con base en un período de referencia
Todas las explotaciones deberán pagar una tasa que aumentará si no cumplen con los requisitos establecidos.
Aquellas explotaciones que reduzcan su censo por debajo del límite podrán recibir un incentivo económico, financiado con los ingresos generados por esta tasa.
Se estima que alrededor de 60.000 vacas serán sacrificadas como resultado de esta medida, aunque algunas podrían ser exportadas a otros países de la UE o a terceros mercados.

Cierre de explotaciones (2,5 millones de kg de fosfatos)
Para fomentar la reducción del censo ganadero, se implementarán tres rondas de licitación en las que el incentivo económico disminuirá progresivamente para incentivar una adopción temprana de la medida.
Se ofrecerá una prima de 1.200 € por vaca sacrificada, además de un pago adelantado vinculado al derecho de fosfato.
El coste total del plan se estima en 50 millones de euros.
Se prevé que esta medida conlleve el sacrificio de aproximadamente 100.000 vacas.
Ajustes en la alimentación (1,7 millones de kg de fosfatos)
Se establecerán restricciones en la formulación de los piensos para reducir la cantidad de fósforo ingerido por los animales:
El contenido medio de fósforo en la ración deberá limitarse a 4,3 g/kg de pienso.
Se establecerá una relación fósforo/proteína del 2,2 % con el fin de optimizar la eficiencia nutricional y reducir la excreción de fosfatos al medio ambiente.
La gestión eficiente del fósforo en la alimentación animal es clave para lograr un equilibrio entre productividad y sostenibilidad. En este contexto, se cabe destacar los siguientes puntos clave:
Optimizar la formulación de las raciones mediante una alimentación de precisión permite reducir significativamente la excreción de fósforo en el estiércol, minimizando su impacto ambiental sin afectar la producción.
Ajustar los niveles de fósforo en la dieta para evitar excesos innecesarios, manteniendo el rendimiento productivo de los animales y optimizando los costes de producción.
Evaluar correctamente los niveles de fósforo en los forrajes para ajustar su inclusión en la dieta y evitar sobrealimentación con fuentes minerales.
Considerar el plan de abonado de las explotaciones, asegurando una gestión eficiente de los purines y estiércoles para optimizar el uso del fósforo en los suelos.
Implementar un plan de reducción del aporte de fósforo, garantizando siempre que las necesidades nutricionales de los animales estén cubiertas.
En definitiva, el desafío actual no solo radica en cubrir los requerimientos del ganado, sino en hacerlo de manera eficiente y responsable, alineando la producción animal con los criterios de sostenibilidad y rentabilidad.








Israel Flamenbaum Ph. D. Cow Cooling Solutions, Ltd, Israel
israflam@inter.net.il www.cool-cows.com

Monitorizar y transmitir en tiempo real y de forma continua la temperatura corporal de las vacas es hoy una realidad, permitiendo optimizar los tratamientos de enfriamiento aplicados a los animales y maximizando sus beneficios.

Este artículo recopila el conocimiento acumulado en Israel durante los últimos años a partir de experiencias y estudios centrados en el monitoreo de la temperatura corporal de las vacas mediante registradores de datos intravaginales, así como los beneficios obtenidos a la hora de afrontar la carga de calor del verano.
En uno de mis primeros proyectos de refrigeración, llevado a cabo en una granja lechera de gran escala, utilizamos registradores de datos intravaginales durante el verano en un grupo de 30 vacas, enfriadas mediante una combinación de humectación y ventilación forzada en la zona de espera antes de cada sesión de ordeño.
Enfriamiento
Inicialmente, las vacas eran enfriadas durante un total de 3 horas/día, distribuidas en intervalos de 1 hora cada 8 horas.
En la Gráfica 1 se muestra la temperatura corporal de las vacas sometidas a este tratamiento.
Las vacas bajo este régimen de enfriamiento no lograron enfriarse adecuadamente, manteniendo durante gran parte del día una temperatura corporal superior a 39,0 °C, considerado el umbral a partir del cual se experimenta estrés por calor.
Temperatura vaginal (°C)

Enfriamiento
Ante los resultados insatisfactorios, optamos por duplicar el tiempo de enfriamiento, ofreciendo a las vacas tratamientos más frecuentes (uno cada 4 horas, 6 horas acumulativas al día).
Enfriamiento
Gráfica 1. Temperatura vaginal a lo largo del día en vacas enfriadas durante 3 horas acumulativas diarias, distribuidas en intervalos de una hora antes de cada sesión de ordeño, cada 8 horas (las columnas azules indican los periodos de enfriamiento).
Enfriar a las vacas durante 6 horas acumulativas al día, con sesiones de 1 hora cada 4 horas, permitió mantener su temperatura corporal dentro de rangos normales durante todo el día.
Los resultados obtenidos se presentan en la Gráfica 2.
41,0
Enfriamiento
Enfriamiento
Enfriamiento
Enfriamiento
Enfriamiento
Enfriamiento
Gráfica 2. Temperatura vaginal a lo largo del día en vacas enfriadas durante 6 horas acumulativas al día, con sesiones antes y entre cada ordeño, distribuidas cada 4 horas. Las columnas azules indican los tratamientos de enfriamiento realizados antes de cada ordeño, y las columnas naranjas representan los tratamientos efectuados entre las sesiones de ordeño.
Paralelamente, se realizó un estudio en la granja lechera experimental del Ministerio de Agricultura de Israel.
En este estudio, se comparó el comportamiento y rendimiento de vacas enfriadas durante 3,5 horas acumulativas al día, distribuidas en 5 sesiones de enfriamiento de 45 minutos cada una, con el de vacas enfriadas durante 6 horas acumulativas al día, repartidas en 8 sesiones de enfriamiento de 45 minutos cada una (Honig et al., JDS 95:3737, 2012). Los resultados obtenidos se detallan en la Tabla 1.
Los datos presentados en la Tabla 1 confirman, tal y como se evidenció en el estudio previo, que enfriar a las vacas durante 6 horas acumulativas al día les permite mantener una temperatura corporal normal a lo largo de toda la jornada.
Esto se traduce en un incremento en el tiempo de descanso y rumia, así como en un mayor consumo de alimento y una producción de leche más elevada.


Los datos presentados reflejan los resultados obtenidos mediante un enfriamiento intensivo, un enfoque que puede ser difícil de implementar en granjas lecheras comerciales habituales.
En la práctica, muchas de estas granjas no logran resultados tan efectivos y las vacas suelen pasar varias horas al día con temperaturas corporales por encima del umbral de estrés por calor.
Tabla 1. Consumo de alimento, producción de leche, tiempo de descanso y rumia en vacas sometidas a 5 tratamientos de enfriamiento diarios, acumulando 3,5 horas al día (5T), frente a 8 tratamientos diarios, acumulando 6 horas al día (8T).





Sin embargo, no cabe duda de que el monitoreo continuo de la temperatura corporal es una herramienta valiosa para optimizar los tratamientos de enfriamiento. A pesar de ello, persiste la interrogante sobre el impacto que puede tener en las vacas permanecer con temperaturas corporales por encima del umbral durante parte del día.













































Un estudio realizado por investigadores del Instituto de Investigación del Ministerio de Agricultura de Israel exploró la relación entre el número de horas diarias que las vacas experimentan estrés por calor y sus características de fertilidad al ser inseminadas en verano.
Se insertaron registradores de datos intravaginales en 32 vacas de cada una de 12 granjas ubicadas en la región central de Israel. Los datos se recopilaron durante dos periodos de 3 días cada uno, entre julio y septiembre.
En base en la información obtenida, las granjas se clasificaron en tres grupos según el número de horas diarias en las que la temperatura vaginal de las vacas superaba el umbral de 39 °C:
Periodo corto
Periodo medio
Periodo largo
Las tasas de concepción correspondientes a las inseminaciones realizadas en ese verano para los tres grupos de granjas se resumen en la Tabla 2.
Periodo por encima del umbral Horas > 39 °C
Tabla 2. Tasa de concepción en vacas inseminadas durante el verano en granjas clasificadas según el tiempo que las temperaturas vaginales excedieron el umbral de 39 °C: periodos de tiempo corto, mediano y largo.
Las granjas cuyas vacas mantuvieron una temperatura corporal superior al umbral durante 4,4 horas al día lograron una tasa de concepción en verano del 33 %, casi el doble en comparación con las granjas donde las vacas experimentaron 9,7 horas al día con temperaturas corporales por encima del umbral. Este nivel de 33 % de tasa de concepción es similar al obtenido en granjas con "buen enfriamiento" en Israel, donde el índice de relación de producción de leche entre verano e invierno era cercano a 1,0 (Famenbaum et al., J. of Reproduction and Development Vol. 56, 2010) y la tasa de concepción en verano fue menos de 10 puntos porcentuales inferior al nivel alcanzado en invierno.

Sin embargo, la pregunta persiste:
¿Pueden las vacas que permanecen en completo confort térmico (por debajo de 39 °C durante las 24 horas del día) cerrar completamente la brecha en la tasa de concepción entre el invierno y el verano?
Responder a esta cuestión requeriría monitorear la temperatura corporal de un gran número de vacas en diferentes condiciones.
La ampliación del uso de tecnologías avanzadas para el monitoreo continuo de la temperatura corporal en un gran número de vacas, junto con la capacidad de procesar y transmitir estos datos de forma digital, tiene un enorme potencial para optimizar la eficacia de los tratamientos de enfriamiento.
Además, permitirá responder a la pregunta de si las vacas pueden tolerar, durante ciertas horas del día, temperaturas corporales por encima del umbral sin que esto afecte negativamente su rendimiento.
Esta información podría tener un alto valor económico, ya que ayudaría a reducir el tiempo de operación de los sistemas de enfriamiento, disminuir los costes asociados y, en última instancia, mejorar la rentabilidad de las granjas lecheras.
Monitoreo continuo de temperatura en vacas: clave para afrontar el estrés por calor DESCÁRGALO EN PDF





Servicio Técnico de Quimunsa


En las granjas de ganado vacuno, ovino y caprino, la presencia de moscas no solo genera molestias, sino que también afecta a la sanidad animal y la eficiencia productiva. Además de causar estrés y reducir la ingesta de alimento, estos insectos pueden transmitir enfermedades, comprometiendo el bienestar de los animales y la bioseguridad de las instalaciones.



Masterfly® Bait ofrece una solución eficaz y de larga duración, atrayendo y eliminando rápidamente a las moscas con una sola aplicación que mantiene su efecto hasta 8 meses.
Su innovadora formulación, que combina un potente insecticida con atrayente feromona, lo convierte en una herramienta clave para el control integrado de plagas en el sector de los rumiantes.
Moscas hematófagas: algunas especies, como la mosca de establo (Stomoxys calcitrans), se alimentan de sangre, causando dolor y un estrés aún mayor en los animales.
Anemia y debilidad: las picaduras frecuentes pueden generar anemia en los animales, debilitándolos y haciéndolos más vulnerables a enfermedades.

ralentiza su crecimiento y disminuye la producción de carne.

Ocasionan malestar en los animales por:
Irritación constante: las especies que no pican, como la mosca doméstica (Musca domestica), se alimentan de secreciones oculares y nasales de los cerdos, lo que causa incomodidad y estrés.
Interrupción del descanso: las moscas alteran los patrones de descanso de los animales, afectando su bienestar y crecimiento.
Heridas e infecciones: algunas especies se alimentan de las supuraciones de heridas, dificultando su cicatrización y favoreciendo infecciones secundarias.
Favorecen la propagación de enfermedades:
Vectores de patógenos: las moscas pueden transportar virus, bacterias, parásitos y hongos en sus patas y piezas bucales, contaminando alimento, agua y superficies dentro de la granja.
Transmisión de enfermedades: son responsables de la propagación de patologías como miasis, mastitis y enfermedades entéricas.
Afectación a la salud humana: al actuar como vectores de enfermedades zoonóticas, las moscas pueden transmitir infecciones desde los animales a los trabajadores de la granja.
Las moscas representan un problema recurrente en las granjas, afectando al bienestar animal, la bioseguridad y la productividad. Por ello, la implementación de medidas higiénicas, físicas y químicas es esencial para su prevención y control.
MEDIDAS HIGIÉNICAS
Gestión de residuos orgánicos
El manejo adecuado de excrementos y restos de alimento es fundamental para reducir la atracción de moscas por lo que se recomienda:
Retirar periódicamente el estiércol y almacenarlo en áreas alejadas de la zona de producción.
Implementar sistemas de compostaje o tratamiento de purines para minimizar su impacto.
Evitar la acumulación de alimento en descomposición.

Limpieza y desinfección
Establecer un protocolo de limpieza regular para todas las áreas de la granja.
Utilizar desinfectantes eficaces en superficies donde puedan proliferar larvas.

Mantener drenajes y fosas sépticas en óptimas condiciones para evitar charcos que faciliten la reproducción de moscas.

MEDIDAS FÍSICAS
Barreras físicas
Instalación de mallas mosquiteras en ventanas y aberturas para impedir el acceso de insectos.
Uso de cortinas plásticas en accesos para minimizar la entrada de moscas.
Control ambiental
Mejorar la ventilación en las instalaciones para reducir la humedad y el calor, condiciones favorables para la reproducción de moscas.
Manejar adecuadamente el nivel de humedad en el suelo y en los espacios donde se almacena alimento.
Uso de larvicidas para el control en las zonas húmedas.
Uso de insecticidas adulticidas de contacto para aplicación sobre las superficies.
Uso de cebo atrayentes para atraer y eliminar las moscas.
Para el control de moscas mediante medidas químicas, el cebo con atrayente Masterfly® Bait es una herramienta sencilla y con garantía de resultados.

El control de moscas es indispensable para garantizar una producción eficiente y cumplir con los estándares sanitarios exigidos por la industria.
Masterfly® Bait actúa atrayendo y eliminando rápidamente a las moscas adultas, reduciendo significativamente su población.

Masterfly® Bait es una solución altamente efectiva para el control de moscas que reduce de forma rápida su población con efecto prolongado en el tiempo.
Con una sola aplicación, su acción se mantiene activa hasta 8 meses, ayudando a reducir significativamente la presencia de las moscas en las explotaciones ganaderas y evitando los inconvenientes y costes asociados a su proliferación.
Este producto se ha diseñado específicamente para combatir de manera eficiente la infestación de moscas en instalaciones ganaderas, donde su presencia representa un problema serio para la sanidad y el bienestar animal.
Masterfly® Bait garantiza una protección rápida, eficaz, duradera y de sencilla aplicación.
Las ventajas de Masterfly® Bait son excepcionales:
Compuesto con DINOTEFURAN, molécula insecticida de última generación de alta eficacia.
Contiene feromona como atrayente para atraer irresistiblemente a las moscas.
Su eficacia es de larga duración, hasta 8 meses.
Sus resultados ultra rápidos, en pocas horas.
Masterfly® Bait es el cebo para moscas con la mayor persistencia del mercado, elimina eficazmente hasta 8 meses.





(Musca domestica) y mosca de establo (Stomoxys calcitrans) demuestran que el producto es altamente eficaz para el control de ambas especies durante períodos de hasta 8 meses.
¡Masterfly® Bait es una solución eficaz para el control de moscas de larga duración y sencilla aplicación!
mes 1 mes 2 mes 3 mes 4 mes 6 mes 8 mes 10
Duración en meses
Mosca doméstica Mosca de establo
Gráfica 1. Eficacia del Dinotefuran en el control de Musca domestica y Stomoxys calcitrans a lo largo del tiempo. Se observa una alta mortalidad sostenida en ambas especies durante un período de hasta 8 meses.
pintar pequeños cuadrados de aproximadamente 30 x 30 cm sobre material plástico o madera no absorbente. Una vez secos colgarlos en las paredes.

Masterfly® Bait facilita placas con agujeros diseñadas para facilitar su aplicación y colocación en distintas superficies, ya sea de forma fija o colgante.
Masterfly® Bait está disponible en envases de 125 g y 500 g
El control de moscas en granjas porcinas requiere un enfoque integral basado en la higiene, el manejo de residuos, la implementación de barreras físicas y medidas químicas.
La combinación de estas estrategias reduce significativamente la presencia de estos insectos, mejorando la sanidad y el bienestar animal, además de contribuir a una producción más eficiente y sostenible.










Las moscas eran un problema para la salud de los animales y el rendimiento de la granja. Entonces llegó Masterfly Bait, la solución definitiva: 8 meses sin moscas.
Rápido
Su efecto se percibe de inmediato
Infalible
Eficacia hasta 8 meses
Fácil
Aplicable por pintado Sin desalojo


8 MESES SIN MOSCAS


Diego Calvo Director de Reysa
La gestión de envases y residuos en el sector ganadero y agroalimentario se enfrenta a cambios significativos con la entrada en vigor de nuevas normativas.
Aunque los conceptos de economía circular y ecodiseño pueden parecer ajenos al día a día de una granja, entender cómo estas obligaciones afectan a productores y poseedores de residuos es esencial para adaptarse al nuevo escenario legislativo.
Últimamente, hemos estado viendo diferentes artículos de opinión, webinars y anuncios referentes a las obligaciones surgidas tras la entrada en vigor de:

El RD 1055/2022 de envases y residuos de envases.
La Ley 7/2022 de Residuos y Suelos Contaminados para una Economía Circular.
ACCEDER AL RD 1055/2022
ACCEDER A LA LEY 7/2022

Los objetivos que se mencionan con frecuencia, como la reducción de vertidos, el aumento del reciclado, el ecodiseño o la economía circular, pueden resultar algo abstractos o poco habituales para quienes no trabajan directamente en el ámbito medioambiental y cuya actividad principal se desarrolla en una granja. Surgen entonces preguntas como:

¿Cuáles son las fechas límite para adaptar mi empresa a la nueva normativa?
¿Me afecta si no envaso ningún producto?
¿Qué es un SCRAP y qué distingue a un productor de un poseedor de producto?
¿Qué diferencias hay entre los SCRAPS y cuál es el más adecuado para mi empresa?
¿Qué debo incluir en mis facturas y qué costes debo planificar?
SCRAPS: ¿qué son y cuándo un envasador o productor de producto debe adherirse?
Un SCRAP es un Sistema Colectivo de Responsabilidad Ampliada del Productor.
Según el RD 105/2022, todo productor de producto debe formar parte de un SCRAP o, alternativamente, establecer un SIRAP (Sistema Individual de Responsabilidad Ampliada del Productor).
Sin embargo, el SIRAP resulta poco viable económicamente para la mayoría de empresas, por lo que adherirse a un SCRAP es la opción más lógica para los productores de producto.
Los productores de producto pondrán en el mercado envases de un solo uso o envases reutilizables, en cuyo caso deberán adaptarse a Sistemas de devolución y retorno (SDR).
Diferencias entre los SCRAPS
Cuotas de inscripción: existen SCRAPS con inscripción gratuita, mientras que otros tienen cuotas que van desde 350 € hasta 2.000 €.
Aunque todos los actores acabamos estando implicados de una u otra forma, conviene aclarar a quién afecta qué en nuestro sector.
Enfoque sectorial o multisectorial: aunque algunos SCRAPS están más diseñados para sectores específicos, es probable que a largo plazo todos operen de forma multisectorial y estén disponibles para cualquier área geográfica.

¿Mejor
SCRAPS nuevos o provenientes de sistemas existentes?
Han surgido tanto SCRAPS completamente nuevos como otros derivados de asociaciones sectoriales o sistemas colectivos ya existentes, especialmente en el ámbito de residuos domésticos o específicos, como los RAEES o los aceites usados.
Aunque algunos SCRAPS nuevos pueden carecer de experiencia directa en ciertos ámbitos, todos cuentan con suficiente conocimiento del sector medioambiental para garantizar su funcionalidad.
¿A cuál adherirse si se es envasador o productor de producto?
La elección del SCRAP dependerá en gran medida de las características de la empresa y los envases que gestiones.
Entre las opciones disponibles están, por ejemplo, ECOLEC, ECOVIDRIO, PROCIRCULAR, CARTON CIRCULAR, IMPLICA, AEVAE, SIGFITO, ENVALORA, ECOEMBES, GENCI, PUNTO GRETA o RECYCLIA.
Algunos SCRAPS comenzaron su proceso de autorización antes que otros y, aunque actualmente solo unos pocos han recibido autorización definitiva por parte del Ministerio, se espera que todos estén plenamente operativos en el corto plazo.
Para tomar la mejor decisión, se pueden considerar los siguientes aspectos:
Hay SCRAPS con inscripción gratuita, mientras que otros requieren pagos iniciales que oscilan entre los 350 € y los 2.000 €.
COMPATIBILIDAD SECTORIAL
Aunque algunos SCRAPS están enfocados inicialmente a sectores específicos, todos acabarán siendo multisectoriales y operarán en cualquier área geográfica.
Algunos sistemas provienen de asociaciones o sistemas colectivos ya existentes, lo que puede ser una ventaja en términos de experiencia y funcionamiento.
Sin embargo, incluso los SCRAPS nuevos cuentan con suficiente conocimiento del sector medioambiental para garantizar su eficacia.
La elección de un SCRAP adecuado dependerá de las necesidades operativas, presupuesto y del sector en el que opere tu empresa. Comparar las características y ventajas de cada sistema permitirá cumplir con las obligaciones legales de forma eficiente.



El productor de producto se refiere a los envasadores, incluyendo a empresas como fábricas de pienso, compañías que fabriquen o envasen productos veterinarios, comercios minoristas, establecimientos mayoristas, empresas de distribución y, en general, cualquier negocio que venda productos envasados a sus clientes.
Es importante no limitarse a pensar únicamente en envases primarios, como los sacos en los que se empaqueta un pienso.
Registro obligatorio: deben inscribirse en el Registro de Productores de Producto del MITECO.
Información en facturas: es necesario incluir en las facturas el número de inscripción asignado en dicho registro (ENV/año/XXXXXXXXX).
Contribución al SCRAP: a partir del 1 de enero de 2025, las facturas deben reflejar la contribución al SCRAP de manera claramente diferenciada del resto de conceptos. Para ello, es necesario adaptar el software de facturación de la empresa y automatizar este proceso.
Adhesión a un SCRAP: es obligatorio formar parte de un Sistema Colectivo de Responsabilidad Ampliada de Productor.
También están incluidos los envases secundarios y terciarios, como:
Las cajas en las que se colocan los paquetes.
Los palets utilizados para organizar envíos.
Las bolsas, cartones, el film o el fleje empleados para garantizar que los productos transportados (ya sean fabricados por la propia empresa o no) lleguen en buenas condiciones al cliente.
Declaraciones anuales: cada año, deben facilitar información sobre los envases puestos en el mercado. En el caso de que se gestionen menos de 15 toneladas, es posible optar por una declaración simplificada.
En resumen, las empresas que se consideran Productores de Producto serán las más afectadas por esta ley, asumiendo la mayor parte de las obligaciones administrativas y operativas requeridas.

Plazos para inscribirse como productor de producto del MITECO y en un SCRAP
Desde el 1 de enero de 2025, es obligatorio cumplir con todas las disposiciones de esta Ley.
Aunque la Administración ha permitido prórrogas durante dos años y la inscripción en el Registro de Productores de Producto en el Ministerio sigue abierta, quienes aún no lo hayan hecho deben regularizar su situación lo antes posible.

El poseedor final del residuo: impacto en las granjas

El ganadero no es productor de producto, es siempre poseedor final del residuo, ya que en sus instalaciones suelen generarse residuos (cajas de cartón, film, big bags vacíos, palets, garrafas, IBCs, etc.).
No obstante, muchas veces entran en esta categoría otras empresas, como fábricas de pienso, sobre las que recae la doble figura de productor de producto (por lo que envasa) y poseedor final del residuo (por los residuos afectados por esta ley generados en sus instalaciones).
El poseedor final seguirá trabajando del mismo modo que hasta ahora con su gestor de residuos habitual, segregando correctamente sus residuos.
Sin embargo, adicionalmente, deberá informar a un SCRAP con el que firme un acuerdo voluntario sobre la correcta gestión que hace de sus residuos a través de su gestor de residuos habitual, enviando los documentos de identificación de residuos que éste le entrega.

Es importante diferenciar estos residuos de otros habituales en la granja que no se ven afectados por esta normativa, como agujas, vacunas, medicamentos, baterías, fluorescentes, productos caducados o restos de obras. En estos casos, no será necesario realizar ninguna acción adicional.

La gestión de la documentación será un aspecto clave, ya que gran parte de los procesos deberá realizarse a través de plataformas web de los SCRAPS. Por ahora, estos sistemas no son completamente automáticos, lo que añade una carga administrativa considerable.
En algunos casos, será el poseedor final del residuo (como el ganadero) quien deba adjuntar los Documentos de Identificación de Residuos que justifican la correcta gestión realizada, mientras que, en otros, esta tarea recaerá directamente sobre el gestor de residuos.
Para el ganadero, este proceso puede resultar engorroso, ya que implica conectarse a la plataforma, acceder mediante identificación y subir archivos escaneados.

Aunque los SCRAPS ofrecen una bonificación por la información enviada, estas suelen ser bajas, insuficientes para compensar el tiempo y los recursos necesarios para realizar este proceso. Además, en estos momentos, pocos SCRAPS han hecho públicas sus tarifas, lo que genera incertidumbre
Nueva normativa de envases y residuos: ¿cómo afecta al sector ganadero y a los productores?
DESCÁRGALO EN PDF
Por otro lado, surge la preocupación de que esta gestión documental podría derivar en duplicidad de información, ya que distintos actores de la cadena (Administración, SCRAPS, gestores, OCAs, certificadoras, etc.) podrían requerir datos similares en un sector que ya está altamente regulado y sujeto a inspecciones habituales.
En cualquier caso, será necesario adaptarse progresivamente a este nuevo marco legislativo, integrando estas tareas adicionales en la operativa habitual.
Conclusión: adaptarse a los nuevos tiempos
En definitiva, dado que los ganaderos continuarán gestionando sus residuos de la misma manera con sus gestores habituales, respetando las frecuencias y procedimientos establecidos para cada tipo de residuo, los SCRAPS no interfieren directamente en la operativa diaria ni aportan cambios significativos en términos de bioseguridad, por lo que esta nueva legislación no afectará sustancialmente a las explotaciones ganaderas.
En cambio, los productores de producto sí deberán realizar ajustes importantes para cumplir con la normativa, incluyendo la adaptación de sus procesos para incluir declaraciones anuales, actualizaciones en las facturas y la obligatoriedad de adherirse a un SCRAP.
Como horizonte temporal el año 2025 se prevé divulgativo y de más paulatina adecuación. Estas modificaciones serán esenciales para garantizar el cumplimiento total del marco legislativo.

Carlos Carbonell y Laura Elvira
Equipo Técnico de MSD Animal Health

La diarrea neonatal es una enfermedad multifactorial compleja y constituye la principal causa de problemas de salud y mortalidad en terneras lactantes.
Tanto ganaderos como veterinarios están familiarizados con las pérdidas económicas asociadas a:
Las bajas de terneras.
Las visitas veterinarias.
Los tratamientos.
El tiempo de mano de obra.
En cambio, no existe tanta consciencia sobre las repercusiones de la diarrea a corto plazo, con una menor ganancia de peso y mayor riesgo de sufrir neumonía posterior, y a largo plazo debido al retraso reproductivo y la menor producción de leche en primera lactación (Abuelo et al., 2021; Schinwald et al., 2022).
Entre las principales causas infecciosas de diarrea, nos encontramos con virus, bacterias y parásitos, siendo Escherichia coli, rotavirus, coronavirus y Cryptosporidium parvum los agentes más frecuentemente involucrados (Cho & Yoon, 2014).
Estos patógenos pueden actuar tanto de manera aislada como en infecciones mixtas en las que se incrementa la gravedad clínica y amplía el rango de edad de los animales afectados. Por ello, establecer un diagnóstico adecuado será clave a la hora de decidir las medidas de prevención más efectivas.

A la hora de prevenir la diarrea causada por C. parvum, más conocida como criptosporidiosis, os presentamos las principales preguntas y respuestas que os pueden surgir:
Se trata de una enfermedad causada por el parásito Cryptosporidium spp., un protozoo digestivo de amplia distribución mundial.
Dentro del género Cryptosporidium se incluyen al menos 44 especies de protozoos gastrointestinales que pueden afectar a numerosos mamíferos, incluido el hombre (Chalmers et al., 2019), ya que es una zoonosis.
En el caso de los terneros, C. parvum es la principal especie causante de diarrea, afectando especialmente a los terneros entre la segunda y tercera semana de vida (Shaw et al., 2021).
¿QUÉ DISTRIBUCIÓN TIENE LA CRIPTOSPORIDIOSIS?
El parásito C. parvum tiene una amplia distribución mundial y está presente en rebaños de leche y de carne (Santin, 2020).
En un estudio efectuado en granjas de la cornisa cantábrica, se identificó a Cryptosporidium en un 54,5 % de las explotaciones y en el 77 % de los terneros con diarrea entre 7-21 días (López-Novo y col., 2019).
54,5 %
77 % 7-21 días
¿CUÁLES SON LOS SIGNOS CLÍNICOS DE LA CRIPTOSPORIDIOSIS EN TERNEROS?
Los terneros afectados presentan una diarrea leve a grave que suele ser insidiosa y durar bastantes días.
En algunos casos, también pueden presentar fiebre leve, deshidratación, apatía, anorexia y pérdida de peso (a corto y largo plazo).
Si bien la criptosporidiosis no suele ser mortal, puede llegar a serlo cuando no aplicamos un tratamiento adecuado de forma precoz, incrementando las tasas de mortalidad neonatal.
¿POR QUÉ TIENE CRYPTOSPORIDIUM UNA DISTRIBUCIÓN TAN AMPLIA?
¿CUÁL ES EL SECRETO DE SU ÉXITO?
El secreto del éxito de este parásito está en las características de su ciclo:
Son necesarios muy pocos ooquistes del parásito para que un ternero se infecte. Se ha visto que tan solo 7-17 ooquistes son capaces de desencadenar el cuadro clínico (Zambriski y col, 2013).
Se disemina muy rápidamente entre terneros (un ternero con diarrea por criptosporidios puede eliminar entre uno y diez millones de ooquistes por gramo de heces durante aproximadamente 12 días) y dentro del propio ternero afectado (se multiplica en las células intestinales con numerosos ciclos de replicación y puede causar también la autoinfección en el mismo animal).
Los ooquistes que se excretan con las heces son ya directamente infectantes, por lo que un ternero afectado disemina rápidamente la enfermedad a través de sus heces a otros terneros que puedan estar en contacto.
Alta resistencia ambiental, hasta un año en condiciones óptimas, siendo además muy resistentes a gran parte de los desinfectantes.
Localización intracelular, pero extracitoplasmática en las células intestinales, lo que explica porque pocos fármacos presentan actividad frente a este protozoo y la dificultad de su control y prevención.
Más de 10.000 millones de ooquistes/día

Figura 1. Ciclo de vida de Cryptosporidium. Un número mínimo de 17 ooquistes puede causar infección en terneros. Tras la colonización del intestino, la excreción de ooquistes comienza entre 4 y 12 días después de la infección y puede durar 1-2 semanas, con una eliminación masiva de más de 10.000 millones de ooquistes por día, facilitando la transmisión del parásito en el ambiente.
El parásito se transmite por vía fecal-oral, lo que significa que la infección se produce cuando los ooquistes son ingeridos por vía oral, contagiándose el ternero cuando ingiere las heces de un animal infectado.
Debido a esto, la transmisión puede ocurrir directamente (desde otro ternero, animal o humano infectado) o indirectamente (a través de la contaminación fecal en el entorno inmediato, el agua, el alimento o los fómites).
Uno de los principales factores de riesgo es la presión ambiental, que puede ser mitigada mediante estrategias de control adecuadas.
Solo 17 ooquistes necesarios para la infección
Excreción de ooquistes se inicia los 4-12 días y dura 1-2 semanas
Una vez se produce la infección, el parásito provocará diarrea debido a que, al replicarse, ocasiona daños en las células intestinales del ternero. Además, las células destruidas se restituyen a base de células inmaduras con menor capacidad digestiva y de absorción, lo que:
Prolonga la duración de la diarrea.
Penaliza el crecimiento a pesar de tratar adecuadamente al ternero.
La mayoría de los terneros con criptosporidiosis superarán la infección con éxito.
Sin embargo, incluso después de la recuperación, los efectos a largo plazo son frecuentes, como una menor ganancia de peso y menor producción láctea en la primera lactación. También es posible que el animal vuelva a infectarse con Cryptosporidium spp. en un futuro, pero afortunadamente no es probable que el ganado adulto sea sintomático.

Una vez el ternero enferma, la criptosporidiosis se maneja principalmente con terapia de soporte (p. ej., rehidratación con electrolitos o fluidos).
Sin embargo, una vez se diagnostica el problema en la granja, podemos complementar esta estrategia con tratamientos metafilácticos con antimicrobianos, como la halofuginona (Halocur®), a los nuevos terneros nacidos durante siete días, lo que nos ayudará a controlar la infección.
Sin embargo, siempre es preferible prevenir antes que tratar, aplicando medidas higiénicas y la vacunación para el control de la criptosporidiosis, reservando los tratamientos a una segunda línea de defensa.
Eliminarlo completamente de una granja es casi imposible debido a su alta resistencia ambiental. Sin embargo, se pueden implementar estrategias de control para minimizar su impacto:
Prácticas de higiene adecuadas en la granja (limpieza y/o rotación de parideras, desinfección del material de alimentación, tratamiento del agua, etc.) que permitan reducir la presión de infección.
Inmunidad específica mediante la aplicación de un completo plan vacunal que incluya la vacunación de las madres para proteger a los terneros frente a la criptosporidiosis.

Sí, en el año 2024 se lanzó la primera vacuna disponible a nivel mundial frente a la criptosporidiosis, Bovilis Cryptium® de MSD Animal Health.

Esta nueva vacuna que se puede administrar al mismo tiempo que Bovilis® Rotavec® Corona para conseguir una protección integral que incluya los cuatro patógenos más frecuentes de la diarrea neonatal de los terneros: C. parvum, coronavirus, rotavirus y E. coli.
La vacuna se aplica a las madres durante el último tercio de gestación y actúa incrementando los niveles de anticuerpos específicos en el calostro y leche de transición de la madre.
Esta protección llegará al ternero a través de la ingestión del calostro y la leche de transición. De este modo, mediante la transferencia de inmunidad pasiva de la madre, el ternero recibirá protección frente al parásito.
La protección de los terneros dependerá de la adecuada ingestión de calostro y leche de transición procedente de madres vacunadas.
Se recomienda que todos los terneros sean alimentados con calostro y leche de transición durante los primeros 5 días.
¡Consulta con tu veterinario sobre cómo incluir la vacunación frente a la criptosporidiosis en el programa vacunal de tu granja!
La leche de transición se define como la secreción que produce la vaca durante la transición entre el calostro del primer ordeño hasta el sexto u octavo ordeño cuando ya se considera leche (Fischer et al., 2019).
Todos conocemos la importancia del encalostrado en la salud de los terneros, pero quizá nos hemos focalizado tanto en el manejo del calostro durante las primeras 24h de vida, que nos hemos olvidado de la importancia de continuar administrando la leche de transición durante los primeros días de vida, tal y como se hacía de forma tradicional en las granjas.
¿Qué beneficios tiene su uso?
A nivel nutricional, la leche de transición contiene más sólidos y mayor cantidad, tanto de grasa como de proteína, proporcionando más energía metabolizable que ayuda a la ternera a la adaptación a un ambiente más frío que el del útero materno.
A nivel de salud intestinal, la leche de transición juega un papel muy importante, justo en el momento de mayor riesgo de diarreas.
Ayuda en el establecimiento de poblaciones bacterianas beneficiosas que conformarán la microbiota intestinal (Hromádková et al., 2020).
Aporta una gran cantidad de inmunoglobulinas que actúan a nivel de la luz intestinal, lo que denominamos inmunidad lactogénica (Schalich et al., 2021).

Prevenir la criptosporidiosis en terneros no solo es posible, sino esencial para reducir su impacto en la salud y el rendimiento productivo.
El control efectivo de esta enfermedad pasa por una combinación de estrategias: higiene rigurosa, manejo adecuado del calostro y leche de transición, y ahora, con el respaldo de la vacunación, una nueva herramienta para reforzar la inmunidad de los terneros desde sus primeros días de vida.
Consultar con el veterinario sobre las mejores prácticas y aplicar un enfoque integral permitirá minimizar las pérdidas y mejorar el bienestar animal en la granja.
Bibliografía disponible solicitando a los autores
El secreto está en el ciclo: decálogo sobre la criptosporidiosis en los terneros DESCÁRGALO EN PDF
PARA MÁS INFORMACIÓN SOBRE LA VACUNA FRENTE A LA CRIPTOSPORIDIOSIS


Silvia del Caso, Cristina Baselga y Gema Chacón
Exopol S.L.

La patología digestiva es una de las principales enfermedades que afectan a los terneros de primeras edades.
Es multifactorial pues su aparición depende de la virulencia y patogenicidad de los agentes infecciosos implicados y de diversos factores predisponentes, como condiciones ambientales desfavorables o manejos inadecuados (higiene deficiente, mal encalostramiento, etc.).




En los últimos años, debido al aumento de las resistencias antimicrobianas y a la carencia de nuevas moléculas antibióticas, se han creado proyectos centrados en el enfoque One Health.
Estos proyectos promueven el uso prudente y responsable de fármacos para preservar su efectividad en animales y personas y reducir la propagación de las resistencias.
En este sentido, el estudio de la sensibilidad antibiótica de las bacterias implicadas en cada caso clínico es una gran herramienta para el veterinario en la elección del tratamiento más idóneo.

En este artículo presentaremos los resultados de frecuencia de detección de patógenos y de pruebas de sensibilidad antibiótica en casos clínicos digestivos de bovino recibidos en el laboratorio Exopol entre 2019 y 2024.
Los patógenos digestivos más prevalentes en terneros lactantes se muestran en la Tabla 1.
La edad a la que aparece el cuadro diarreico, los signos clínicos y la morbilidad y mortalidad nos ayudarán a realizar un diagnóstico presuntivo.
Torovirus, Norovirus genotipo 3 y Nebovirus se consideran virus entéricos emergentes y se ha descrito su participación en procesos digestivos como agentes primarios.
Sin embargo, es complicado evaluar su implicación en condiciones de campo porque suelen aparecer junto a otros patógenos digestivos.
La monitorización de estos agentes y el estudio de su patogenicidad permitirán en el futuro determinar su verdadera implicación.


Tabla 1. Principales patógenos digestivos en terneros lactantes y sus características.
Naturaleza Patógenos Edad
Coronavirus bovino 1-2 semanas
Vírica

Bacteriana
Rotavirus tipo A 1-2 semanas
Pestivirus (BVD) 5– 35 días
Clostridium perfringens 24h28 días
Escherichia coli 24h –7 días
Salmonella sp. 10-90 días
Cryptosporidium parvum 5-30 días
Parasitaria
Eimeria sp >3 semanas
Tipo de diarrea Otros
Amarillenta con moco
Explosiva de color amarillento, grisáceo o verdoso con moco o sangre
Verde-sanguinolenta
Hemorrágica
Explosiva de color amarillento
Acuosa, con fibrina o sangre
Pastosa de color amarillento
Oscura y sanguinolenta con moco o sangre
Deshidratación Elevada Media
Deshidratación Elevada Elevada
Fiebre, anorexia, letargo, úlceras en digestivo Elevada Media
Anorexia, fiebre Baja Elevada
Deshidratación, postración Elevada Elevada
Deshidratación, anorexia, fiebre, tenesmo Variable Elevada
Tenesmo Elevada Baja
Retraso en el crecimiento, fiebre, tenesmo Elevada Baja
Una correcta toma de muestras es clave para un diagnóstico concluyente.
Se deben seleccionar animales:
Con sintomatología digestiva.
Que no hayan recibido antibioterapia.
Que se encuentren en la fase inicial de la infección (los animales crónicos pueden desarrollar infecciones secundarias).
Sintomatología digestiva
Sin antibioterapia
Animales seleccionados
Las muestras digestivas a recoger pueden ser:
Heces tomadas directamente del recto.
Hisopos rectales
Tracto digestivo donde se observen lesiones en caso de tener bajas

Fase inicial de infección
Hisopo rectal Heces
Muestras de elección
Tracto digestivo
En el laboratorio se utilizan distintas técnicas diagnósticas para identificar al agente causal de las patologías entéricas:
PCR a tiempo real (qPCR): permite la detección y amplificación de regiones específicas del genoma de los diferentes patógenos obteniendo un resultado cuantitativo.
Aislamiento bacteriano: la obtención de cepas bacterianas mediante microbiología permite realizar el estudio de sensibilidad antibiótica (Imágenes 1 y 2).
Prueba de sensibilidad antibiótica: la más utilizada es el antibiograma en disco (Kirby-Bauer), en la que se expone el aislamiento bacteriano a una concentración estandarizada de antibiótico.
Se mide el halo de inhibición del crecimiento bacteriano alrededor del disco (Imagen 3) y, según los puntos de corte clínicos la bacteria será:
Sensible.
Sensibilidad intermedia.
Resistente.

Imagen 1. Aislamiento de Escherichia coli en Agar MacConkey a las 24 horas de incubación a 37 °C.
Imagen 2. Crecimiento de Salmonella en Agar XLD incubado a 37 °C en aerobiosis.
Imagen 3. Antibiograma de Kirby-Bauer. Los 4 discos de antibiótico superiores presentan halos de inhibición. En los dos discos de la parte inferior no hay halo, indicando que la cepa es resistente a esos antibióticos.


El análisis de muestras obtenidas en casos clínicos proporciona una visión detallada de la presencia y distribución de agentes patógenos involucrados en procesos digestivos en bovino.
A través de la técnica de qPCR se han identificado los principales agentes digestivos y, en algunos de ellos sus factores de virulencia. Realizando un aislamiento bacteriano, se han identificado las principales bacterias implicadas y ha permitido realizar un estudio de su sensibilidad antibiótica.
En la Gráfica 1 se observa un elevado porcentaje de muestras positivas a Clostridium perfringens y E. coli, al ser bacterias comensales del tracto digestivo, es necesario estudiar la presencia de factores de virulencia para evaluar su implicación clínica (Gráfica 2).
Salmonella spp., que se detecta en un 12-15 % de las muestras, tiene una relevancia clínica importante debido a la gravedad de los síntomas y a la dificultad para controlarlos.
Las siguientes gráficas muestran los datos obtenidos en los últimos años, permitiendo detectar tendencias en la frecuencia de detección de distintos patógenos y evaluar su impacto clínico. Además, se presentan los resultados de sensibilidad antibiótica de Escherichia coli y Salmonella sp., fundamentales para la toma de decisiones terapéuticas y el diseño de estrategias de control más eficaces. Porcentaje de muestras positivas a cada agente del panel de qPCR para procesos digestivos en bovino
El agente vírico más prevalente es Rotavirus tipo A, mientras que el porcentaje de detección de Coronavirus bovino ha ido en aumento con el paso de los años y el de Pestivirus (BVD) ha ido disminuyendo.
Los virus entéricos emergentes (Torovirus, Norovirus genotipo 3 y Nebovirus) están presentes en un 20-30 % de las muestras en los últimos años, aunque hay que realizar más estudios para determinar su relevancia.
Gráfica 1. Porcentaje de muestras positivas a cada agente del panel diagnóstico digestivo de qPCR de Exopol. No se disponen de resultados de Salmonella sp. de los años 2019 y 2020.


Cryptosporidium parvum es el parásito más detectado, superando el 50 % de las muestras positivas en 2020 y 2021, aunque se observa una disminución en la frecuencia de detección en los últimos 3 años.
Eimeria sp. en el 2024 presenta un aumento de la detección, debemos continuar recopilando

El estudio de factores de virulencia de E. coli muestra que en torno al 30 % de los casos presentan cepas ETEC (enterotoxigénicas), positivas a las toxinas STa, STb y/o LT.
Las cepas ETEC con F5 han sido las más frecuentes en las diarreas colibacilares según la práctica clínica, sin embargo, las encontramos en un porcentaje muy bajo, este cambio seguramente sea debido al uso habitual de la vacunación.
Las cepas con la fimbria F17 se detectan en un mayor porcentaje, sobre el 90 %.
Aproximadamente el 60 % de las muestras analizadas son positivas a cepas EPEC (enteropatógenas, gen eae) y en un 30 % de los casos observamos presencia de cepas STEC (productoras de shigatoxinas STX1 y STX2) y EHEC (enterohemorrágicas, gen eae y STX1 o STX2).
Porcentaje de muestras positivas a cada factor de virulencia de E.coli
Gráfica 2. Porcentaje de muestras positivas a E. coli y a sus distintos factores de virulencia incluidos en el panel de qPCR de Exopol para procesos digestivos en bovino.



Clostridium perfringens tipo A (produce únicamente toxina α) es el toxinotipo más predominante. El toxinotipo D (toxina α y ε) y E (toxina τ) también se detectan, pero con una incidencia mucho menor. La toxina β-2 se detecta en un 50 % de las muestras positivas, las cepas capaces de producirla tienen una mayor virulencia.
Porcentaje de muestras positivas a cada toxina del panel de qPCR - Toxinas de C. perfringens

Gráfica 3. Porcentaje de muestras positivas a las distintas toxinas que puede producir Clostridium perfringens, todo ello incluido en el panel de qPCR de Exopol para procesos digestivos en bovino.

La espectinomicina es el único antibiótico de categoría D (de primera elección) eficaz frente a más del 50 % de cepas testadas (Gráfica 4).
La combinación con lincomicina se utiliza en infecciones digestivas por E. coli aunque las lincosamidas (lincomicina, clindamicina) no tienen actividad frente a la mayoría de las bacterias gram negativas como E. coli y Salmonella combinación de espectinomicina y lincomicina presenta un amplio espectro de acción.
La mayoría de los antibióticos de la categoría C presentan porcentajes de cepas sensibles alrededor del 60 %.
El caso más preocupante es el de neomicina (aminoglucósido) con una disminución significativa de la sensibilidad en los últimos años posiblemente ocasionada por su frecuente uso en otras especies animales.
Otros aminoglucósidos como gentamicina y paromomicina presentan mejores resultados (más del 60 % de cepas sensibles).


B presentan buenos resultados de sensibilidad. Sin embargo, flumequine es eficaz en menos del 40 % de las cepas testadas y enrofloxacino tiene menos del 60% de cepas sensibles.
Porcentaje de cepas sensibles de E.coli
Gráfico 4. Porcentaje de cepas sensibles de E. coli. Se ha evaluado la evolución de la sensibilidad de cada antibiótico a lo largo del tiempo mediante la prueba estadística Chi-cuadrado. Se considera que existen diferencias significativas entre los diferentes periodos de tiempo, si p-valor < 0,05 (*). No se disponen de resultados de paromomicina, cefquinoma, ceftiofur y flumequine de los años 2019 y 2020.
De la categoría D, todos los antibióticos excepto trimetoprim-sulfametoxazol obtuvieron menos del 50 % de cepas de Salmonella sensibles (Gráfica 5). Además, trimetoprim-sulfametoxazol muestra una caída estadísticamente significativa del porcentaje de cepas sensibles en los últimos años.
Los antibióticos de la categoría C presentan mejores resultados, como apramicina, paromomicina, amoxicilina con ácido clavulánico y gentamicina.
Cabe resaltar que la neomicina presenta un descenso estadísticamente significativo de la sensibilidad en los últimos años con solo un 29 % de cepas sensibles en 2023-2024.
Flumequine, de la categoría B, está registrado para el tratamiento de salmonelosis, pero presenta porcentajes de sensibilidad bajos (40 %) en los años 2023 y 2024. El resto de los antibióticos de la categoría B presentan resultados muy buenos de sensibilidad.
Observamos que Rotavirus tipo A es el virus detectado con mayor frecuencia, Cryptosporidium parvum el parásito más relevante y el porcentaje de detección de Eimeria sp. ha aumentado en el último año.
Los factores de virulencia F17 y gen eae de Escherichia coli son los detectados en porcentajes más altos y Clostridium perfringens tipo A es el toxinotipo más frecuente en procesos digestivos.
Las cepas de E. coli analizadas presentan bajos porcentajes de sensibilidad frente a la mayoría de los antibióticos de las categorías D y C, pero son mejores en los de categoría B. En el caso de Salmonella sp. se observan mejores resultados de sensibilidad que en E. coli.
En ambos casos es necesario realizar pruebas de sensibilidad antibiótica antes de instaurar un tratamiento.

ACCEDER A BIBLIOGRAFÍA
Porcentaje de cepas sensibles de Samonella sp.
D-AmoxicilinaD-AmpicilinaD-EspectinomicinaD-TetraciclinaD-TrimetoprimsulfametoxazolC-AmoxicilinaconácidoclavulánicoC-ApramicinaC-FlorfenicolC-GentamicinaC-NeomicinaC-ParomomicinaB-CefquinomaB-CeftiofurB-ColistinaB-EntrooxacinoB-Flumequine
Gráfico 5. Porcentaje de cepas sensibles de Salmonella sp. Se ha evaluado la evolución de la sensibilidad de cada antibiótico a lo largo del tiempo mediante la prueba estadística Chi-cuadrado. Se considera que existen diferencias significativas entre los diferentes periodos de tiempo, si p-valor < 0,05 (*). No se disponen de resultados de paromomicina, cefquinoma y flumequine de los años 2019 y 2020.






y mortalidad asociada a la enfermedad respiratoria con otros que conviven sin manifestar una elevada problemática al respecto.


En estas situaciones, la mortalidad directa ocasionada se complementa con la presencia de otro porcentaje variable de animales que evolucionan hacia cuadros de neumonía crónica de muy difícil solución y escasa respuesta terapéutica, independientemente de las medidas que se adopten.

La conclusión es evidente: pérdidas elevadas para las empresas y lotes que, ya desde el primer mes, van a generar pérdidas en su conjunto al final del periodo de cebo, además de requerir un mayor uso de antibióticos, lo que contribuye a la aparición de resistencias en las neumonías crónicas.
A nivel infeccioso, se encuentra un amplio elenco de patógenos que pueden participar en mayor o menor grado en la etiología del complejo, generando infecciones mixtas que responden de manera muy variable a los tratamientos y al resto de medidas de control que se ponen en marcha en los cebaderos. Entre ellos, cabe destacar:
Virus respiratorio sincitial.
Virus Parainfluenza. Coronavirus bovino.
Herpesvirus bovino tipo 1 (BoHV-1), agente causal de la Rinotraqueítis Infecciosa Bovina (IBR).
Virus de la diarrea vírica bovina.
En este complejo contexto, los resultados obtenidos en los últimos años han sugerido el incremento de la participación de Mycoplasma bovis en la etiología del síndrome, tanto a nivel nacional como a nivel internacional.
Esto ha motivado la realización de diversos estudios etiológicos cuyo objetivo principal ha sido establecer su participación y papel epidemiológico real en diversos ámbitos productivos, tanto en terneros mamones como principalmente en terneros pasteros (Becker et al., 2020; Dudek et al. 2020; García-Galán et al., 2020; García-Galán et al., 2021).
Pasteurella multocida.
Mannheimia haemolytica.
Biberstenia trehalosi.
Histophilus somni. Mycoplasma bovis.
La complejidad de funcionamiento del sector del bovino de cebo en las condiciones actuales conlleva que, en muchas ocasiones, por el tipo de oferta y demanda existente, los cebaderos tengan que incorporar animales de muy diversa procedencia , tanto del mercado nacional como del mercado internacional.
En muchos de los individuos que ingresan en los cebaderos se desconocen por completo diversos aspectos que, a priori, son fundamentales para el desarrollo del CRB, por ejemplo:
El correcto encalostramiento de los animales.
Las estrategias de inmunización activa que puedan ayudar a proteger a los individuos antes del ingreso a la etapa de engorde.
1. Los lotes que presentaban una mayor frecuencia de infección por Mycoplasma bovis en el tiempo 0 (a su llegada al cebadero), manifestaban una sintomatología respiratoria más grave y temprana respecto a los lotes donde la presencia del microrganismo no era tan alta o no se detectaba en tiempo 0.
Día 0
2. Se ha detectado en todos los lotes analizados la presencia de Mycoplasma bovis antes de los 15 días de estancia en el centro.
Día 15

Esto, unido al estrés ocasionado por los días de tránsito desde la explotación de origen al destino final o la ausencia de periodos de cuarentena, hace que la formación de lotes de múltiples procedencias se convierta en una auténtica lotería y que, evidentemente, en muchas ocasiones los animales no respondan adecuadamente a las actuaciones sanitarias que se realizan los primeros días de llegada a los cebaderos.
Lo que acontece a lo largo del primer mes de estancia en los centros es fundamental para entender lo que sucede con el CRB y principalmente, diseñar mejores medidas de control.
En este sentido, los trabajos de análisis y seguimiento desarrollados en varios lotes de terneros pasteros sitos en cebaderos de la Comunidad Valenciana y de la Región de Murcia, han evidenciado varios aspectos de interés en relación a la participación de Mycoplasma bovis, que podríamos resumir de la siguiente manera:
3. La frecuencia de la infección por Mycoplasma bovis aumenta progresivamente en los lotes analizados a medida que se prolonga la estancia en los mismos (Gráfica 1)
Días de estancia en cebadero
Frecuencia de infección

M. bovis
4. Se han detectado tres subtipos diferentes a nivel molecular (utilizando el sistema basado en el gen polC, descrito por Becker et al., 2015) de cepas circulantes de Mycoplasma bovis (ST-1, ST-2 y ST-3), detectándose lotes donde las infecciones mixtas con varios subtipos estaban presentes.


Los análisis desarrollados han permitido evidenciar que cuando los terneros llegan a los cebaderos, se identifica de forma directa o indirecta la presencia de un porcentaje variable de individuos que ya llegan con infecciones mixtas bacterianas y/o víricas adquiridas en fases anteriores a su llegada.
2 3 4 5
Gráfica 1. Evolución de la frecuencia de infectados por M. bovis durante el periodo de estudio.
Todo ello, ha permitido obtener conclusiones prácticas al respecto del control del síndrome respiratorio que parecen orientarnos hacía la necesidad de aplicar las medidas correctoras mucho antes del comienzo de la sintomatología, independientemente de lo que suceda en periodos de tiempo más avanzados o cuando ésta se hace más evidente.
¡No solo hablamos de lo que sucede cuando los animales llegan a los cebaderos!
De hecho, en los lotes en los que se ha hecho el seguimiento y estaban más afectados, la sintomatología respiratoria puede presentarse prácticamente desde su entrada en los cebaderos o, como muy tarde, en la primera semana, pocos días después del comienzo del cebo.
Es evidente que un síndrome plurietiológico y multifactorial tan complejo como el CRB no puede eliminarse en su totalidad.
Pero igual de contundente que esta afirmación, lo es el hecho de que las medidas preventivas o de control a efectos de limitar su efecto en los animales deberían comenzar antes de que los animales lleguen a la etapa final que constituye el cebo.


En la misma línea, es bastante probable que, si los terneros estuvieran bien inmunizados y preparados para este proceso, y además se enfrentaran solo a la infección por Mycoplasma bovis, las consecuencias sanitarias y económicas de la infección serían mucho menores.
En los cebaderos, el movimiento de individuos con diferentes características epidemiológicas es continúa.
Estos animales llegan con un “historial de encuentros previos” con agentes infecciosos que puede ser muy diferente entre ellos, a lo que, además, se une el hecho de la interacción posterior con alguno o algunos de los microorganismos que circulan en el cebadero.
Llegar lo mejor preparado para este desafío es fundamental…
Los resultados obtenidos por nuestro equipo de trabajo parecen indicar que la infección previa con algunos virus respiratorios como el virus respiratorio sincitial representan un factor predisponente para padecer el CRB en sus formas más complejas en el cebadero, además de predisponer al animal a la infección por Mycoplasma bovis.
No debe resultarnos extraño este efecto sinérgico entre ambos microorganismos, ya que la presencia de ambos -y otros- y su interacción con el sistema inmunitario del hospedador es habitual.
No obstante, falta mucha información en relación con los mecanismos de patogenicidad que utilizan estos microorganismos o la interacción que se establece entre ellos, incluyendo, como se ha visto recientemente, el intercambio de material genético entre diferentes bacterias que puede desencadenar efectos fenotípicos impredecibles.
Si muchos terneros llegan infectados a los cebaderos, tampoco es descartable que la infección pueda estar presente en muchos de los colectivos de origen, tanto de los terneros pasteros como de los terneros mamones.
Debería analizarse lo que acontece en los centros de concentración o a lo largo del proceso de transporte de los animales de un lugar a otro, donde la transmisión, refiriéndonos además a animales muy estresados, no es descartable.
No hay datos al respecto, pero lo que sí parece claro es que todo lo que hagamos para reforzar la inmunidad de los animales los hará menos sensibles a los efectos posteriores del CRB.

Hay que garantizar un buen encalostrado y alimentación de los animales, a lo que parece que hemos de añadir, sin duda, la inmunización activa frente a los agentes víricos más importantes, responsables de predisponer negativamente a los terneros a la infección por Mycoplasma bovis y/o algunos de los otros patógenos oportunistas que aprovechan la situación para incrementar el daño a nivel respiratorio de los animales afectados.

Una vez que aparece la sintomatología respiratoria en las primeras semanas del cebo, la solución es compleja.
Evidentemente, el uso de los antimicrobianos es necesario, pero desafortunadamente, en ocasiones, limita escasamente los efectos de la patología.

Desafortunadamente, los datos obtenidos indican la elevada circulación del subtipo ST-3 en los colectivos españoles, lo que implica un gran impacto en el diagnóstico y, sobre todo, en el control de la enfermedad, al tratarse de cepas multirresistentes a prácticamente todos los tratamientos existentes.
Ello puede explicar la variabilidad de eficacia de los tratamientos incluso dentro de un mismo lote, y la falta de eficacia de estos en muchos casos.
Hablábamos antes de la existencia de tres subtipos, al menos, de Mycoplasma bovis. Pues bien, todos ellos presentan elevados valores de resistencia frente a diferentes grupos de antimicrobianos, entre los que podemos incluir:
Los macrólidos.
Las tetraciclinas.
Las lincosamidas.
Las quinolonas.
En referencia a las quinolonas, la caracterización molecular de los aislamientos ha evidenciado hasta ahora importantes diferencias fenotípicas en relación con su sensibilidad, con altos valores de CMI asociados principalmente al ST3, a diferencia de algunos aislamientos del subtipo ST-1 y la práctica totalidad de los clasificados como ST-2, que parecen manifestar una buena sensibilidad.


Es evidente que la presencia y participación de M. bovis en el CRB es importante y que, tanto a nivel nacional como internacional, está considerado uno de los agentes patógenos más importantes, sin menospreciar su importancia en los rebaños productores de leche, que debe ser también analizada en profundidad (Dudek et al. 2020). A nuestro juicio, algunas de las actuaciones en las que hay que trabajar deben centrarse en los siguientes aspectos:


Reducción de presión de infección (limpieza, desinfección, mínimo número de orígenes posible, cuarentena).




Extremar las medidas de limpieza y desinfección, además de establecer espacios y tiempos de cuarentena obligatorios.

Siempre que sea posible, se deberían incorporar animales de una sola explotación, y si no lo es, hay que incorporarlos del menor número posible de granjas de procedencia en los lotes a cebar.






















































































Imagen 1. El control del CRB debe comenzar con un buen preacondicionamiento de los terneros que incremente su resistencia.
Es fundamental abordar la sanidad de modo obligatorio en origen para incrementar la resistencia a la llegada de los animales a cebadero (preacondicionamiento, con un mínimo programa sanitario y nutricional) (Imagen 1).

Hay que inmunizar activamente de modo obligatorio y correcto (con las dosis necesarias) a los terneros al menos frente a los virus respiratorios, fundamentalmente frente al virus respiratorio sincitial (VRS).
¿Te imaginas que fuera realidad la reducción del uso de antibióticos para el control de Mycoplasma bovis?

Presentamos PROTIVITY® liofilizado y disolvente para suspensión inyectable para bovino: la primera vacuna viva modificada frente a Mycoplasma bovis.
Es hora de cambiar las reglas del juego en tu granja con PROTIVITY® Más información en www.zoetis.es/protivity















Es importante registrar y analizar los datos sanitarios directos en cada cebadero, teniendo en cuenta diferentes parámetros (como mínimo, % morbilidad, % crónicos, % mortalidad, pues hay otros indicadores), identificando y priorizando los patógenos:
Más prevalentes.








Es fundamental trabajar con el sector en el ámbito del diseño y mejora de las instalaciones, y el diseño y manejo de los lotes, teniendo en cuenta específicamente la aplicación de los periodos de cuarentena necesarios o la aplicación progresiva de las medidas de bioseguridad ya existentes en otros sectores productivos. Todo ello, con el objetivo de caracterizar el riesgo de cada una de ellas.

Con pobre respuesta terapéutica.
Con alto riesgo de cronificación.
Con alto consumo de antimicrobianos.









Puede ser recomendable, en lotes problemáticos a priori realizar un análisis microbiológico de muestras respiratorias de un porcentaje de los individuos el día 0, a efectos de disponer de información de la presencia de agentes infecciosos y su sensibilidad bacteriana a los antimicrobianos.
Mycoplasma bovis incrementa su papel clínico-epidemiológico en el complejo respiratorio bovino
DESCÁRGALO EN PDF






AGRADECIMIENTOS
Los trabajos que se están desarrollando se enmarcan en el Proyecto financiado por la Comunidad Autónoma de la Región de Murcia a través de la convocatoria de Ayudas a proyectos para el desarrollo de investigación científica y técnica por grupos competitivos, incluida en el Programa Regional de Fomento de la Investigación Científica y Técnica (Plan de Actuación 2022) de la Fundación Séneca-Agencia de Ciencia y Tecnología de la Región de Murcia (Proyecto SENECA 22034/PI/22), con la colaboración directa de las siguientes empresas: Juan Jiménez García S.A.U.; BOS NOSTRUM S.L., ADS de bovino de Lorca y Cargill SLU CPN España.
David Guallar1, Ibai Tamayo1, David López1, María Villacampa1, Maialen Zinkunegui1, Héctor
Ruiz1,2 y Pablo Quílez1,2.
1Servicio Clínico de Rumiantes, Facultad de Veterinaria de Zaragoza, España.
2Departamento de Patología Animal, Universidad de Zaragoza, España.

El linfoma en ovino es una patología poco común con una sintomatología inespecífica que puede asemejarse a otras enfermedades, siendo el aumento de tamaño de los nódulos linfáticos en distintas regiones del cuerpo un hallazgo sugestivo de esta patología. La anatomía patológica e inmunohistoquímica son fundamentales para el diagnóstico definitivo, pero, ante la ausencia de tratamiento, la eutanasia es la opción más adecuada, tanto desde el punto de vista económico como para el bienestar del animal.
A continuación, se presenta un caso clínico de una oveja adulta de raza Lacaune remitida al Servicio Clínico de Rumiantes de la Facultad de Veterinaria de Zaragoza con una grave sintomatología respiratoria, cuyo estudio permitió llegar al diagnóstico definitivo.
En octubre de 2023, el Servicio de Experimentación Animal (SEA) de la Universidad de Zaragoza remitió al Servicio Clínico de Rumiantes (SCRUM) de la Facultad Veterinaria de Zaragoza una oveja adulta de raza Lacaune, de aptitud lechera y seis años de edad.
El animal presentaba una evidente sintomatología respiratoria que comprometía su vida. La oveja se encontraba estabulada permanentemente en un lote, en régimen intensivo, dentro de las instalaciones del SEA en la Facultad de Veterinaria.
A su llegada, el animal fue sometido a una exhaustiva exploración clínica.
Se identificó un cuadro respiratorio caracterizado por una disnea inspiratoria grave acompañada de un ronquido fuerte y constante, además de que, en ocasiones, respiraba por la boca, lo que indica un marcado esfuerzo inspiratorio.
Ante la sospecha de un cuadro neumónico, se inició un tratamiento.
Sin embargo, el empeoramiento clínico y la gravedad que presentaba el animal obligaron a su remisión para un estudio más completo.

Asimismo, se observó en la exploración la presencia de una linfadenomegalia generalizada, así como un aumento del tamaño de la ubre que, a la palpación se percibía simétrica, caliente y dura, con presencia de nódulos en el parénquima.
De forma simultánea, también se apreció tos fuerte y productiva, junto con una secreción nasal seromucosa bilateral.
1. Patologías que afectan a las vías respiratoria altas
La sintomatología que presentaba el animal, en especial la marcada disnea inspiratoria, orientaba el diagnóstico hacia una patología respiratoria de vías altas. En base a esta sospecha, se incluyeron varias patologías en el diferencial:
Rinitis Crónica Proliferativa (RCP), causada por Salmonella enterica subsp. diarizonae serovar 61:k:1,5,(7) (Meehan et al., 1992).
Esta patología individual, provoca una inflamación progresiva de los cornetes nasales ventrales, caracterizada por disnea inspiratoria, ronquidos y secreción nasal mucosa densa que puede ser unilateral o bilateral. En ocasiones, pueden observarse los nódulos linfáticos regionales aumentados.
Basándose en la experiencia y la clínica, parecía la opción más factible y, debido a la gravedad del cuadro, se tomó una muestra y se procedió a tratar al animal frente a ello con antiinflamatorios y marbofloxacino, tratamiento de elección frente a este agente (Rubira et al., 2019).
Oestrosis, miasis cavitaria causada por las larvas de la mosca Oestrus ovis, considerada la rinitis más importante y prevalente en áreas geográficas cálidas y secas (Gracia et al., 2010).
Suele estar asociada a la cría en condiciones extensivas o de pastoreo, siendo una patología colectiva, de rebaño (Lucientes et al., 1998). Los animales presentan descarga nasal mucosa o purulenta, incluso hemorrágica (Gracia et al., 2010).
Adenocarcinoma Nasal Enzoótico (ANE), tumor contagioso causado por un betaretrovirus conocido como ENTV (Enzootic Nasal Tumor Virus) que afecta a ovejas (ENTV-1) y cabras (ENTV-2).
Esta patología provoca una transformación neoplásica de las células epiteliales secretoras del cornete etmoidal, dando lugar a disnea inspiratoria, descarga nasal serosa continua e, incluso, exoftalmos y deformación craneal debido al crecimiento del tumor (De las Heras et al., 2003; Walsh et al., 2013).
Rinopatía obstructiva asociada al hongo Pseudopithomyces chartarum, una patología colectiva caracterizada por disnea inspiratoria causada por una obstrucción nasal crónica, total o parcial, a nivel de las narinas, además de una hepatopatía (De las Heras et al., 2022).
De forma simultánea, la tos fuerte y productiva parecía indicar también afección en vías respiratorias bajas, por lo que el diferencial incluyó también otras patologías como:
Complejo Respiratorio Ovino (CRO), causado por bacterias como Mannheimia haemolytica, Pasteurella multocida, Bibersteinia trehalosi y Mycoplasma spp que actúan de manera oportunista (Lacasta et al., 2019).
Adenocarcinoma Pulmonar Ovino (APO), un tumor pulmonar causado por el retrovirus ovino Jaagsiekte (JSRV), miembro de la familia Retroviridae (De las Heras et al., 2005; Griffiths et al., 2010) que da lugar a cuadros graves en fases avanzadas, con secreción nasal y severa dificultad respiratoria.
Neumonía gangrenosa, causada generalmente por la inhalación de cuerpos extraños y posterior reacción cuando estos se alojan en el pulmón (Lacasta et al., 2019).
Neumonía verminosa o neumonía granulomatosa, enfermedad producida por nematodos pulmonares, aunque es más típica de de sistemas de producción no intensivos.
Tabla 1. Diagnóstico diferencial basado en los signos clínicos observados durante la exploración.
3. Patologías que ocasionan linfadenomegalia generalizada
El animal presentaba una linfadenomegalia generalizada, lo que podría sugerir la presencia de procesos sistémicos, como: Infección generalizada o abscesos.
Neoplasias, como el linfoma multicéntrico, caracterizado por el aumento de tamaño de los linfonodos (Johnstone y Manktelow, 1978).
Linfadenitis caseosa superficial, causada por la bacteria Corynebacterium pseudotuberculosis.
La linfadenomegalia también se observó a nivel de la ubre, lo que, sumado a los hallazgos en la palpación de la ubre y la aptitud lechera del animal, no permitía descartar la presencia de mamitis de etiología bacteriana (Smith et al., 2015).
Disnea inspiratoria y ronquido
Rinitis Crónica Proliferativa (RCP)
Adenocarcinoma Nasal
Disnea mixta y tos productiva Linfadenomegalia generalizada
Complejo Respiratorio Ovino (CRO) Linfadenitis caseosa
Enzoótico (ANE) Adenocarcinoma Pulmonar Ovino (APO) Neoplasia
Oestrosis Neumonía gangrenosa Abscesos generalizados
Rinopatía obstructiva crónica asociada a Pseudopithomyces chartarum
Neumonía verminosa o granulomatosa
Se realizó una hematología en la que se observó una anemia microcítica e hipocrómica acompañada de neutrofilia, eosinopenia, linfopenia y trombocitopenia, lo que era sugestivo de un proceso inflamatorio crónico o neoplásico.
También se realizó un estudio termográfico debido al valor diagnóstico de esta prueba en el diagnóstico de procesos respiratorios en vías altas (Ferrer et al., 2021).
La termografía evidenció la presencia bilateral de zonas incrementadas de temperatura a nivel de las fosas nasales, tanto en vista frontal como lateral, sugestivas de una inflamación.
Debido a la clínica y al resultado de las pruebas complementarias, especialmente el de la termografía, se decidió realizar una toma de muestras a nivel nasal para confirmar o descartar la presencia de un cuadro de RCP, principal sospecha.
Los resultados negativos obtenidos en PCR frente a su agente causal, descartaron dicha enfermedad, motivo por el que se interrumpió el tratamiento antibiótico, manteniéndose el antiinflamatorio debido a la mejoría clínica que presentó el animal tras su aplicación.
El animal terminó falleciendo debido a la gravedad del cuadro clínico que presentaba, por lo que se realizó un minucioso estudio postmortem por parte del Departamento de Patología Animal de la Universidad de Zaragoza.
Se observó una hiperemia nasal generalizada acompañada de una masa tumoral de unos 6 cm de diámetro que afectaba a la mucosa nasal de la mitad caudal del cornete ventral y del cornete medio (Imagen 1).

Se observó otra masa de aspecto similar en el linfonodo retrofaríngeo que presentaba linfadenomegalia, de un color blanquecino brillante (Imagen 2).

En la cavidad torácica, los nódulos linfáticos bronquiales y mediastínicos presentaban una linfadenomegalia de aspecto similar rodeando la tráquea (Imagen 3).

Imagen 3. Linfadenomegalia en nódulos linfáticos bronquiales y mediastínicos.
En la cara dorsal del lóbulo diafragmático derecho del pulmón también se observaron nodulaciones duras y blanquecinas de unos 2 cm, rodeadas concéntricamente de otras similares, pero de menor tamaño (<0,5 cm) (Imagen 4). Estas nodulaciones profundizaban al corte, siendo macroscópicamente compatibles con un APO o bien con nódulos satélites de las masas observadas en los distintos nódulos linfáticos.

4. Nódulos en lóbulo diafragmático compatibles con APO.
A nivel de la ubre, los nódulos linfáticos mamarios presentaban una acusada linfadenomegalia (25x15 cm aproximadamente) con un aspecto blanquecino brillante a la sección (Imagen 5), aunque la glándula mamaria no mostraba lesiones aparentes.

Imagen 5. Marcada linfadenomegalia en nódulos linfáticos mamarios.
La histopatología de las masas a nivel nasal y en los nódulos linfáticos reveló que estaban compuestas por un gran número de células de aspecto tumoral, compatibles con linfocitos neoplásicos en patrón sólido que alteraban profundamente la arquitectura tisular normal, siendo un aspecto compatible con un linfoma (Imagen 6).

Imagen 6. Patrón sólido de linfocitos que invade el tejido nasal (400x).

Por el contrario, los nódulos encontrados en el lóbulo diafragmático del pulmón correspondían a un aumento en el tamaño de los neumocitos tipo 2, lo que indicaba una hiperplasia de la pared alveolar. Además, se observó fibrosis, un notable infiltrado inflamatorio compuesto por macrófagos y otras células, así como zonas de necrosis (Imagen 7), patrón característico del APO.

Imagen 7. Hiperplasia de la pared alveolar e hipertrofia de los neumocitos tipo 2, imagen compatible con un APO (400x).
El linfonodo mamario mostraba también la presencia de linfocitos tumorales que producían la destrucción de los territorios orgánicos y el aumento del mismo denotando la hiperplasia del órgano (Imagen 8). Por otro lado, la glándula mamaria también presentaba una invasión de los linfocitos neoplásicos a pesar de su aspecto macroscópico aparentemente sano.


Imagen 8. Nódulo linfático mamario con presencia de linfocitos tumorales e invasión del vaso sanguíneo.
El diagnóstico final incluyo la presencia de dos tipos de neoplasia simultáneamente, un APO y un linfoma multicéntrico.
Se realizaron pruebas inmunohistoquímicas para conocer la serie de linfocitos predominante en el linfoma de tal manera que, debido a su reacción con el biomarcador Pax5, presente en las membranas de los linfocitos B, se consideró como un linfoma multicéntrico de tipo B.

El linfoma multicéntrico es una enfermedad común en especies domésticas como el perro o el bovino de aptitud lechera. Incluso en caprino se ha descrito algún caso esporádico. Sin embargo, en ovino se han descrito muy pocos casos, por lo que se considera como una enfermedad rara.
En pequeños rumiantes los signos clínicos son inespecíficos e incluyen pérdida progresiva de peso, caquexia, apatía, fiebre y disnea (Digrassie et al., 1997; Anjos et al., 2010; Rego et al., 2015), produciéndose el diagnóstico tras el sacrificio y de forma accidental.
No obstante, las biopsias del líquido peritoneal o de los nódulos linfáticos aumentados, donde se puede observar un elevado número de linfocitos inmaduros y degenerados, puede ser útil para el diagnóstico in vivo de este tipo de enfermedades (Santos et al., 2020).
En cuanto a la progresión de los tumores, un estudio de matadero realizado por Jonhstone y Manktelow (1978), en el que se analizaron la localización de los tumores de 22 ovejas con linfoma maligno, encontró que la forma más constante de este linfoma es el aumento de tamaño de los nódulos linfáticos afectados, seguido de la propagación progresiva del tejido neoplásico a otros linfonodos y órganos no linfoides, tal y como se ha visto en este caso en ubre y cornete nasal.
Después de los nódulos linfáticos, el bazo es el segundo órgano más afectado, seguido de su presencia en útero. No obstante, es importante destacar que la propagación a otros órganos a raíz de un linfoma sistémico es muy común, lo que genera un pronóstico muy desfavorable.
Según los criterios de la OMS, adaptados a especies específicas (Valli et al., 2002), la clasificación histopatológica de un linfoma se basa en:
La distribución topográfica.
El inmunofenotipo.
Las características histológicas.
Kiser y Löhr (2017) adaptaron dichos criterios a la especie caprina, clasificándose según:
Distribución (difusa o nodular).
Tamaño y morfología nuclear. Índice mitótico.
En ovino dichos valores podrían verse ligeramente alterados, pero puede emplearse.

En cuanto a la causa del tumor, la mayoría de casos son espontáneos, con un claro componente genético e inmunogénico (Jonhstone y Manktelow, 1978).
No obstante, existen diversos estudios que relacionan el virus de la leucemia bovina (BLV) con la aparición de linfoma multicéntrico maligno en ovino (Murakami, 1994; Kenyon, 1981). Sin embargo, España es libre de BLV. Por ese motivo, se desconoce una causa inductora concreta de la aparición de la neoplasia en este caso.
Siguiendo con el diagnóstico del animal, es importante destacar que, además del linfoma multicéntrico, se localizaron nódulos duros en el lóbulo diafragmático derecho del pulmón que profundizaban al corte, diagnosticados como APO, un tumor de etiología vírica frecuentemente observado en ovino.
Es destacable la confluencia de estas dos patologías, no solo por la baja probabilidad de que un animal presente dos procesos neoplásicos simultáneamente, sino porque Di guardo et al. (1992) describieron un caso de similares características, donde se observó APO junto a linfoma multicéntrico en una oveja adulta de dos años. Por tanto, aunque podría tratarse de una coincidencia, podría existir la posibilidad de que pudiera llegar a existir alguna relación entre ambas patologías.
El tratamiento frente a este tipo de patologías es inviable a nivel comercial en ovino o pequeños rumiantes. En otras especies domésticas, como el perro, la cirugía y tratamientos quimioterápicos son opciones terapéuticas utilizadas (Toyoda et al., 2023). Incluso, la rabacfosamida ha mostrado buen resultado en esta especie (Imveterinaria 2021).
Actualmente no es posible aplicar estos tratamientos en ganadería, por lo que el sacrificio del animal sigue siendo la medida más adecuada para evitar la progresión clínica y el deterioro del animal.
No es posible aplicar medidas preventivas frente a estos tumores, ya que, al igual que la mayoría de las neoplasias, su aparición está influenciada por características genéticas y ambientales, lo que impide establecer una vía preventiva.
Este caso pone de manifiesto la complejidad diagnóstica del linfoma multicéntrico en ovinos y la necesidad de un enfoque clínico y patológico detallado. Aunque no existen opciones terapéuticas viables en la especie, su estudio aporta información valiosa sobre una patología poco frecuente, ayudando a mejorar su reconocimiento y abordaje en la práctica veterinaria.
Álex Gómez1,2, Idoia Glaria3, Irati Moncayola3, Irache Echeverría4, Ana Rodríguez-Largo5, Laura Arriazu3, Ainhoa Calero3, Estela Pérez1,2, Lluís Luján1,2 y Ramsés Reina3
1Departamento de Patología Animal, Universidad de Zaragoza, Zaragoza
2Instituto Agroalimentario de Aragón-IA2, Universidad de Zaragoza, Zaragoza
3Instituto de Agrobiotecnología (CSIC-Gobierno de Navarra), Mutilva Baja
4Departamento de Agronomía, Biotecnología y Alimentación, Universidad Pública de Navarra, Pamplona
5Servei de Diagnòstic de Patologia Veterinària, Departament de Sanitat i Anatomia Animals, Universitat Autònoma de Barcelona, Barcelona

El ectima contagioso (EC) es una enfermedad causada por el virus Orf (ORFV) que afecta, principalmente, a los pequeños rumiantes (Gómez et al., 2024).
La gran prevalencia del EC a nivel mundial y las severas pérdidas económicas que genera en las granjas afectadas la convierte en una de las patologías de los pequeños rumiantes más importantes de la actualidad (Lovatt et al., 2012; Windsor et al., 2017).
El EC se caracteriza por la presencia de pápulas, vesículas y pústulas en el hocico, labio y base de las orejas en dermatitis costrosas proliferativas, actualmente definidas como pseudotumorales (Pintus et al., 2024).


De manera menos frecuente, estas lesiones dérmicas también pueden observarse en otras regiones anatómicas, como los pezones. Asimismo, esta enfermedad causa erosiones y úlceras en la mucosa oral y gastrointestinal (Lacasta et al., 2024).
Las lesiones causadas por ORFV favorecen la aparición de infecciones bacterianas secundarias que incrementan la severidad del cuadro clínico (Haig & Fleming, 1999).
El EC obligatoria de control y prevención específicos.
En algunos países como Australia o Francia, la vacunación se utiliza como medida principal de control en las áreas endémicas. Sin embargo, en España no hay ninguna vacuna registrada frente a ORFV.
En la actualidad, no hay una vacuna universal eficaz y segura frente al EC ya que el ORFV es capaz de evadir el sistema inmune mediante diferentes mecanismos (Bukar et al., 2021; Fleming et al., 2015):
Los genes accesorios, situados en los extremos del genoma de ORFV, codifican proteínas inmunomoduladoras como interferon resistance protein), viral vascular endothelial growth granulocyte-macrophage colony-stimulating factor), y vCBP viral chemokine binding protein inhiben la presentación antigénica y el reclutamiento de los leucocitos a la epidermis y mucosas afectadas.


La infección localizada en células epiteliales de la piel y mucosa oral-gastrointestinal son de difícil acceso para anticuerpos y células inmunitarias como linfocitos T, lo que favorece la persistencia del virus (Bukar et al., 2021; Fleming et al., 2015).
Las diferentes cepas de ORFV pueden presentar mutaciones dando lugar a cambios en la virulencia y patogenicidad que dificulten las estrategias de inmunización (Fleming et al., 2015; Hosamani et al., 2009).
La amplia distribución de esta enfermedad, su repercusión en la viabilidad de las explotaciones y su potencial zoonótico hacen de especial interés el desarrollo de vacunas seguras y eficaces.
Hasta el momento, se han generado diferentes tipos de vacunas frente a ORFV:
Vacunas basadas en costras
Vacunas vivas atenuadas
Vacunas de subunidades
Vacunas de ADN
Vacunas basadas en vectores virales
El objetivo de este trabajo es exponer las ventajas y desventajas de cada tipo vacunal frente al EC.
Un paso esencial en el desarrollo de estrategias vacunales es conocer qué tipo de respuesta inmunitaria se pretende priorizar para conferir el mayor grado de protección posible.
La infección natural induce una respuesta de tipo humoral mediada por anticuerpos que no son capaces de inducir protección frente a la infección, ni eliminación del virus (Buddle & Pulford, 1984; Mercer et al., 1997).
Por lo general, la infección por ORFV no induce títulos altos de anticuerpos neutralizantes. No obstante, algunos estudios demuestran que los animales con alto título de anticuerpos son capaces de recuperarse mejor tras una reinfección (McKeever et al., 1988; Yirrell et al., 1991).
Por lo tanto, el papel de los anticuerpos en el control de esta enfermedad no se conoce por completo. Actualmente, las vacunas vivas atenuadas en cultivo celular son las únicas registradas en algunos países.


Los linfocitos T, tanto CD4+ como CD8+, juegan un papel muy importante en la eliminación del virus (Anderson et al., 2001; Haig, 2006; Haig & McInnes, 2002), siendo la respuesta Th1/ celular la más importante para el control de esta enfermedad.
Adicionalmente, múltiples estudios han sugerido que la estimulación de la respuesta inmune innata en las primeras horas de infección de ORFV es clave en su control inmunológico (Friebe et al., 2004; Haig, 2006).

Vacunas vivas atenuadas en cultivos celulares
Las vacunas basadas en costras requieren del aislamiento y purificación de cepas de ORFV obtenidas de lesiones costrosas proliferativas de corderos o cabritos afectados.
Estas vacunas fueron usadas en 1930 con cierto éxito (Bala et al., 2018; Musser et al., 2008, 2012), pero cayeron en desuso dado sus graves problemas de seguridad como la alta incidencia de lesiones en animales inmunizados, incluso transmisibles a animales no vacunados.
Además, este tipo de vacunas no inducía protección cruzada frente a otras cepas virales y suponían un riesgo de recombinación viral y

Más tarde, se desarrollaron las vacunas vivas atenuadas en cultivos celulares que se basan en virus patógenos atenuados tras numerosos pases de infección en diferentes líneas celulares.
Tras un determinado número de pases los virus comienzan a sufrir mutaciones, algunas de las cuales pueden afectar a los genes de virulencia, impidiendo que induzcan patología in vivo tras su inoculación.
Si bien, son más seguras que las anteriores, inducen una protección parcial, corta (3-6 meses) y no transmisible a las crías a través del calostro (Bath et al., 2005; Bhanuprakash et al., 2012; Friebe et al., 2004; Musser et al., 2008; Onyango et al., 2014; Tan et al., 2009).
Estas vacunas son las que actualmente se encuentran registradas en algunos países como Francia y Australia y están únicamente recomendadas en áreas

En la actualidad se están investigando vacunas vivas atenuadas mediante la deleción dirigida, empleando diferentes técnicas de edición genética, de algunos de los genes patógenos de ORFV (Shen et al., 2023; Zhu et al., 2022).
Hasta ahora, se han generado dos ORFV recombinantes con deleción en dos (vCBP y GM-CSF) y tres (vCBP, GM-CSF y ORFV 121) genes, obteniéndose una protección completa en cabritos frente a la infección por ORFV.
Sin embargo, este tipo de vacunas no ha sido testado en la especie ovina y su protección frente a otras cepas virales requiere de más estudios.

Además, este tipo de virus atenuados puede revertir su virulencia, recombinarse con virus de campo generando nuevas cepas o contaminarse en su producción a nivel de laboratorio (Asín et al., 2021; Buddle & Pulford, 1984).
Una opción más segura consiste en las vacunas no replicativas de subunidades antigénicas o vacunas ADN, basadas en proteínas inmunógenas o genes altamente conservados como ORFV B2L (gen ORFV 011) y ORFV F1L (gen ORFV 059) (Wang et al., 2023; Wassie et al., 2019; Zhao et al., 2011).
Tanto las vacunas de subunidades como regímenes heterólogos con vacunas de subunidades y ADN basadas en estas proteínas han inducido una robusta respuesta inmune humoral y celular específica frente a ORFV en modelos de ratón.

Recientemente, se ha diseñado una vacuna de subunidades frente a ORFV que contiene múltiples epítopos derivados de las proteínas ORFV B2L, F1L y 080 (Pang et al., 2024).
Esta vacuna ha mostrado que es capaz de inducir una respuesta inmune robusta específica en diferentes cultivos celulares. Por tanto, el siguiente paso es determinar si este tipo de vacunas induce protección frente a ORFV en pequeños rumiantes.

Las vacunas basadas en vectores virales se están estudiando ampliamente en la actualidad contra diferentes agentes patógenos. Hasta el momento se han utilizado los virus Vaccinia y Adenovirus como vectores virales para el desarrollo de vacunas frente a ORFV.
La generación de un virus Vaccinia recombinante que expresa múltiples fragmentos del ADN de ORFV ha mostrado una marcada protección en corderos frente a la infección por ORFV (Mercer et al., 1997). No obstante, se desconocen las proteínas inmunógenas responsables de la misma.
El Adenovirus recombinante que expresa las proteínas ORFV B2L y F1L (Wang et al., 2023) posee una menor inmunogenicidad que los regímenes heterólogos basados en vacunas ADN y de subunidades.
En conclusión, la vacunación es la mejor, sino la única medida efectiva para controlar el EC.
Las vacunas vivas atenuadas disponibles no son efectivas y pueden presentar problemas de seguridad.
Las estrategias inmunoevasivas de ORFV complican el diseño de vacunas exigiendo un conocimiento profundo del genoma y de las propiedades inmunogénicas de sus proteínas.
Los vectores basados en el virus murino Sendai (SeV) son conocidos como inductores de respuestas proinflamatorias, antivirales y poseen una alta capacidad de expresión transgénica (Griesenbach et al., 2010).
Recientemente, los autores de este trabajo generaron dos SeV recombinantes que expresaban las proteínas B2L (rSeV-GFP-B2L) y F1L (rSeV-GFP-059).
El vector rSeV-GFP-B2L exacerba la infección por ORFV.
Las ovejas inmunizadas con el vector rSeV-GFP-059 mostraron una protección total frente a la infección por ORFV (Gómez et al., 2023).
Las vacunas basadas en vectores virales se pueden considerar una opción prometedora para el control de ORFV.
Las nuevas estrategias basadas en la biología molecular brindan la posibilidad de generar vacunas recombinantes más seguras y con un espectro inmunológico dirigido.
Las vacunas de subunidades, los regímenes heterólogos de vacunas de subunidades y ADN y las basadas en vectores virales constituyen una opción más segura y eficaz para el futuro control de esta enfermedad.

Vacunación frente al ectima contagioso: Un reto por resolver DESCÁRGALO EN PDF
Xavier Puigvert1, Alba Piqué2, MSc. Anna Aymerich3 y Dr. Carles Gasol4
1Ingeniero Agrónomo, Universidad de Girona
2Veterinaria. Técnica de Proyectos. Asociación de iniciativas Rurales y Marítimas de Cataluña (ARCA)
3Responsable de proyectos de métricas ambientales en Inèdit (Consultoría ambiental)
4Director de desarrollo de negocio en Inèdit (Consultoría ambiental)

En España, al igual que en otros países occidentales, el cierre de pequeños mataderos rurales ha dado paso a instalaciones industriales de gran capacidad, lo que ha modificado significativamente el contexto para el sector ganadero.
Esta transformación ha generado diversos problemas, especialmente en el caso de los pequeños rumiantes, como ovinos y caprinos, cuyo sacrificio en mataderos industriales conlleva múltiples desafíos, tanto logísticos como de bienestar animal.
Como alternativa a esta problemática, se han desarrollado proyectos piloto de mataderos móviles en comunidades como Cataluña.
Estos mataderos permiten el sacrificio de los animales directamente en la explotación ganadera, evitando el estrés derivado del transporte y mejorando su bienestar.
Entre los diferentes pasos de la cadena logística previa al sacrificio, el transporte y la espera pre-sacrificio representan los factores más estresantes.

Se analizó el comportamiento de los ovinos antes y durante su sacrificio en un matadero móvil, comparándolo con un matadero convencional.
La evaluación del bienestar se realizó siguiendo protocolos basados en los informes científicos de la EFSA y las guías de eutanasia y sacrificio humanitario de la AVMA y la HSA (2016).
Los mataderos móviles ofrecen una alternativa viable para pequeñas explotaciones, permitiendo realizar el sacrificio en la misma granja y evitando así el estrés asociado con la carga, transporte y descarga de los animales, además del contacto con individuos desconocidos en los mataderos industriales.
BIENESTAR ANIMAL Y SOSTENIBILIDAD AMBIENTAL: COMPARATIVA ENTRE MATADERO MÓVIL Y CONVENCIONAL
En este proyecto se realizó un estudio observacional del comportamiento relacionado con el estrés durante el manejo del ganado ovino antes y durante el sacrificio en un matadero móvil, en comparación con un matadero convencional.
Se consideraron las diversas fases del ciclo de vida del servicio del matadero: el transporte del animal y las canales, el servicio de sacrificio del matadero móvil, así como toda la infraestructura y consumos energéticos.
Se llevaron a cabo tres visitas en las que se evaluó el bienestar animal en dos momentos clave:
Durante su estancia en el corral y el traslado hasta el matadero móvil.
Durante el aturdimiento y sacrificio.
Además, se tomaron muestras de sangre para medir los niveles de cortisol y se realizó la medición del pH de las canales a los 45 minutos postmortem (en el músculo L. thoracis).
Sostenibilidad ambiental
Para evaluar el impacto ambiental, se calculó la huella de carbono del servicio de matadero móvil y se comparó con la de un matadero convencional mediante el Análisis de Ciclo de Vida (ISO 14040 y 14044).
BIENESTAR ANIMAL ANTES DEL
ATURDIMIENTO Y EL SACRIFICIO

En el matadero móvil, varias fases de manipulación se reducen o eliminan, lo que disminuye significativamente el estrés:
La preparación, carga, transporte y descarga no son necesarias, permitiendo que los animales permanezcan en su entorno habitual hasta el momento del sacrificio.
La espera en el corral y el traslado al área de aturdimiento son mínimos y los animales siguen en su entorno habitual, reduciendo así la ansiedad de los animales.
Para minimizar aún más el estrés, se recomienda reducir el tiempo de espera en remolques o corrales y solo trasladar a los animales cuando el sacrificio esté listo para proceder.
También es fundamental controlar la temperatura ambiental y garantizar un espacio adecuado (sobre todo en el caso de usar remolque para el transporte al punto de sacrificio).
En caso de traslado dentro de la explotación, el camino debe estar libre de obstáculos y correctamente iluminado, evitando cualquier tipo de maltrato o uso de técnicas que generen dolor.
CLAVES PARA GARANTIZAR EL BIENESTAR ANIMAL DURANTE EL ATURDIMIENTO Y EL SACRIFICIO
El aturdimiento se llevó a cabo mediante perno cautivo penetrante, un método que garantiza la pérdida de conciencia sin dolor.
Aunque el matadero móvil dispone de una cornadiza como sistema de restricción mecánico del movimiento del cordero, en los días de la visita no se utilizó, ya que se encontraban en un estado de calma y pudieron ser inmovilizados manualmente antes del aturdimiento.
El Reglamento (CE) 1099/2009 no establece un tiempo máximo entre el aturdimiento y el degüello, pero recomienda que sea lo más breve posible (considerándolo aceptable hasta un máximo de 60 segundos).
En el matadero móvil, este intervalo osciló entre 33 y 57 segundos, con un promedio de 41 segundos y en ninguno de los casos evaluados se observaron indicadores de conciencia durante los tres momentos de evaluación (después del aturdimiento, durante el degüelle y durante el desangrado).

En la Tabla 1 pueden observarse los valores de pH y los niveles de cortisol en los corderos sacrificados en el matadero móvil y convencional.
Los análisis de pH y cortisol revelaron diferencias significativas entre los animales sacrificados en el matadero móvil y los del matadero convencional.
El pH a los 45 minutos postmortem fue 6,25 en el matadero móvil, 0,1 puntos inferior al de los corderos sacrificados en el matadero convencional.
Esta diferencia se debe probablemente a una menor acumulación de ácido láctico postmortem en los animales sacrificados en el matadero móvil. Difícilmente esta pequeña variación tenga alguna repercusión en la calidad de la carne final.
Los niveles de cortisol fueron significativamente menores en los animales sacrificados en el matadero móvil, confirmando un menor nivel de estrés pre-sacrificio.
El estudio analizó datos de 9 explotaciones en Cataluña, con 92 servicios y un total de 676 animales sacrificados.
Los resultados mostraron que el matadero móvil permite reducir la huella de carbono en un 35 % en comparación con los mataderos convencionales.
El transporte es la fase con mayor impacto ambiental, representando alrededor del 80 % del impacto total del servicio de matadero.
Con el matadero móvil, se redujo este impacto en aproximadamente un 40 %, gracias a la disminución de las distancias entre la explotación y el matadero convencional de referencia.
Medias con el superíndice diferente indican diferencias significativas (p>95%)
Tabla 1. Media, error estándar de la media y test de comparación de medias por tipos de matadero.


Transporte animales
Servicio matadero
Restos (incineración)
El matadero móvil se desplaza a la explotación
Los animales se desplazan al matadero convencional
Figura 1. Límites del sistema del estudio ambiental.
El sacrificio en el matadero móvil mejora el bienestar animal al eliminar el estrés del transporte y la manipulación en los mataderos industriales.
Además, la aplicación de buenas prácticas de manejo durante el traslado de los animales desde los corrales de origen hasta el matadero móvil puede reducir aún más el riesgo a padecer situaciones de estrés.
El proceso de aturdimiento y sacrificio con bala cautiva penetrante garantiza la perdida de consciencia sin dolor, asegurando que ningún animal recupera la consciencia antes del desangrado. Evaluación del impacto de los mataderos móviles de cordero en
Transporte canales
Existe obrador en la explotación
Transporte con vehículo propio refrigerado
Se logra una reducción del 35 % en la huella de carbono, principalmente debido a la disminución de las emisiones derivadas del transporte.
Las credenciales de bienestar, calidad, proximidad y reducción de la huella de carbono que proporcionan el sacrificio en un matadero móvil pueden proporcionan una ventaja de marketing en la comercialización de la carne de cordero.
Resultados del proyecto ‘Ensayo, monitorización y escalabilidad de un matadero móvil de ovino y caprino como apoyo al pequeño ganadero y al relieve generacional en el mundo rural’. Proyecto financiado a través de la Operación 16.01.01 (Cooperación para la innovación) a través del Programa de desarrollo rural de Catalunya 2014-2020.
ACCEDER A BIBLIOGRAFÍA






